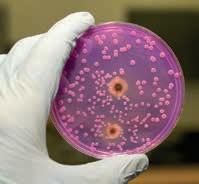

Alitest Soluzioni di Qualità
Alitest, da oltre 22 anni opera nella distribuzione dei Test Rapidi per la rilevazione di inibenti nel latte, continua la propria missione proponendo alcune novità che rafforzano e danno risposte precise al confronto e alle esigenze di un Mercato che deve, che vuole garantire sempre maggiori livelli Qualitativi. In quest‛ottica Alitest è orgogliosa di offrire una gamma completadi prodotti per il settore agroalimentare territoriale.
L’uomo è quello che mangia, Alitest ne garantisce la Qualità.
L’utilizzo di antibiotici per la cura delle malattie degli animali è fondamentale per il loro benessere. Ciò che invece nuoce è il loro abuso, che può favorire lo sviluppo di batteri antibiotico-resistenti che se trasmessi agli esseri umani, possono provocare gravi danni alla loro salute. Appare per tanto evidente l’importanza di poter disporre dei migliori strumenti atti alla rilevazione di residui di tali sostanze potenzialmente cancerogene e dal potenziale allergico presenti dopo il trattamento sanitario e alla veri ca che il periodo di “sospensione” sia stato rispettato. Va tenuto presente al riguardo che lo stesso varia in base alla classe chimica del trattamento delle molecole utilizzate, alle loro caratteristiche farmacologiche, nonché alla genetica dell’animale e delle condizioni ambientali generali. Relativamente ai “migliori strumenti” di rilevazione intendiamo sottolineare l’importanza di Semplici, Sensibili, Accurati e Rapidi Test che diano certezza di risultato ai laboratori di indagine.
Charm MRL Quad1 è certo in tal senso l’unico sul mercato che, rispettando a pieno i limiti di MRL imposti dalla Comunità Europea soddisfa tali esigenze individuando in soli cinque minuti di incubazione:

- la presenza delle principali famiglie di antibiotici (Betalattamici - TetraciclineSulfamidici-Chinoloni).
- Il ceppo completo del Ceftiofur e i suoi metaboliti.
O rendo un’evidenza dei risultati ottenuti, sia visiva che con il sistema di lettura EZ.
Si tratta dell’unico Test che non ha problemi di Cross-Contamination, o erto da una azienda, la Charm Science Inc,


Leader sul mercato internazionale, che vanta una esperienza nel settore latte di oltre 45 anni, superando ogni confronto per a dabilità. Noi dell’Alitest ci pregiamo di rappresentarLa orgogliosi di difendere la Qualità di un prodotto che s da, su tutti i parametri, gli altri sul mercato, senza temere per questo la concorrenza di prezzo.
Lettura immediata Quantitativa per una grande Famiglia di Test
ll programma igiene di Charm basato sul rilevamento dell’ ATP (adenosina trifosfato) fornisce soluzioni rapide per valutare istantaneamente lo stato igienico delle super ci delle tue strutture (sia per il contatto alimentare che non) e soluzioni per testare anche la qualità dell'acqua e altre aree ambientali, compresi i luoghi di cili da raggiungere, nell'intero impianto di lavorazione.
Parliamo delle piastre Peel Plate Charm per le conte microbiologiche.


Oggi sul mercato esistono prodotti simili con caratteristiche laboriose che implicano diverse problematiche, come ad esempio la preparazione del terreno, la cross-contamination, la di usione dell’aliquota e la necessità di molto spazio per l’esecuzione di numerose piastre. Molti sono i test microbiologici, ma pochi sono stati studiati per risolvere pienamente i numerosi problemi riscontrati durante le analisi.
Le Piastre Microbiologiche
Peel Plate Charm presentano le seguenti caratteristiche:
- Pronte all’uso, contenenti un terreno di coltura selettivo per la crescita dei microrganismi.
- Un solo passaggio, basta pipettare il campione da analizzare senza l’utilizzo di tecniche di di usione.
- Progettate e validate per essere sovrapposte.
- Tempi e le temperature di incubazione coincidono con le convenzionali procedure microbiologiche.
-Validate AOAC e NCIMS

UN PERCORSO DI CRESCITA BEN AVVIATO
Il Consiglio Nazionale che ho l’onore di presiedere si appresta a passare il testimone al nuovo Consiglio che, a seguito delle elezioni, sarà nominato proprio in questi giorni. Personalmente chiudo il mio mandato con la consapevolezza, e un pizzico d’orgoglio, per il lavoro svolto dal 2020 ad oggi.
Sono stati tre anni intensi, ma si è trattato senza dubbio di un’esperienza interessante e stimolante per me, che arrivo da una vita di gestione aziendale, così come per i colleghi con i quali ho condiviso un triennio molto impegnativo, fin dall’inizio.
L’insediamento avvenne il 20 febbraio 2020 e la settimana successiva iniziò la crisi del Covid. Fu necessario cambiare da subito l’assetto e le abitudini consolidate in precedenza e si introdusse la convocazione dei Consigli per via telematica con la frequenza fissa di uno al mese.
Un caro saluto e un arrivederci
Il Programma di mandato fu preparato immediatamente con l’obiettivo di mettere il TA al centro delle attenzioni e quindi fu necessario rivedere l’organizzazione interna e le procedure gestionali.
Il nostro è un Ordine piccolo e con una capacità economica limitata, e la prima analisi a cui ci siamo dedicati aveva lo scopo di indagare, partendo da una valutazione il più precisa possibile della base (ovvero, i circa 2.000 iscritti attuali), le potenzialità di allargamento e coinvolgimento dei 20.000 laureati. Abbiamo cercato di capire perché i nostri laureati non fanno l’e-
same di Stato e non si iscrivono, e una prima risposta che possiamo darci risiede nel fatto che, fortunatamente, il mondo del lavoro è ancora molto ricettivo per la nostra figura professionale. Su questo fronte, con le istituzioni e le parti coinvolte, si è lavorato all’ipotesi, ora realizzabile, della laurea abilitante: l’iter è in via di definizione a livello ministeriale, e siamo certi che si tratterebbe di un passo importante, che potrebbe aiutare fortemente questo aspetto.
Un altro punto che è stato al centro delle azioni del Consiglio uscente è stata la divulgazione dell’importanza della formazione post laurea obbligatoria tramite un coordinamento più proattivo con il mondo universitario e della formazione. Ricordiamo che per i TA sono a disposizione i tre pilastri della formazione: quella fornita internamente dall’Ordine sia Nazionale che Regionale, gratuita e a pagamento, e quella erogata tramite le agenzie formative accreditate.
In questo triennio si è lavorato molto anche per rafforzare le relazioni, a più livelli. In primis con gli altri Ordini Professionali all’interno della Rete delle Professioni tecniche e ProfessionItaliane, anche per imparare da altri molto più grandi e organizzati di noi. Ma si è lavorato molto anche sulla valorizzazione del TA a livello di relazione con i Ministeri legati alla nostra professione come Agricoltura, Sovranità alimentare e Foreste e Sanità.
Internamente è stato rafforzato il coordinamento con la Consulta degli 11 Presidenti al fine di promuovere un percorso comune e sempre più integrato che oggi, grazie agli strumenti informatici, sembra molto più facile e agevole da realizzare. Abbiamo inoltre trovato una nuova Sede più economica e usufruibile, con un servizio di segreteria; e abbiamo realizzato anche il nuovo website, rivisto e rinnovato e più user friendly, che dovrà assolvere al servizio di “portale delle necessità” per i nostri iscritti.
In questa fase, l’Ordine Nazionale è in grande salute finanziaria, condizione necessaria per fare delle azioni che richiedono un certo investimento economico, e di cui è ora possibile una pianificazione più precisa.
L’incompiuta che lasciamo è l’attività di divulgazione alle aziende della figura professionale del TA, affinché possano apprezzare il vantaggio di avere TA nelle proprie organizzazioni invece di un più generico “food technologist” o “food engineer”. Da portare a compimento anche l’adesione a una Cassa Previdenziale a vantaggio dei nostri iscritti, ma possiamo dire che siamo alla fine del suo iter istitutivo e che a breve verrà ufficializzata.
L’Ordine in questi tre anni ha perseguito con determinazione il suo percorso di crescita, soprattutto nei termini organizzativi necessari per poter intraprendere le azioni che servono allo sviluppo della categoria. Non abbiamo dubbi circa il fatto che chi raccoglierà il nostro testimone potrà e saprà operare al meglio nell’esclusivo interesse degli iscritti e che quotidianamente lavorerà per garantire la stabilità e lo sviluppo della nostra comunità nazionale OTAN.
Un caro saluto e un arrivederci a qualche occasione d’incontro dei TA.
INNOVAZIONI E BIOTECNOLOGIE AGROALIMENTARI
CULTURE MICROBICHE “MADE IN ITALY” PER LA VALORIZZAZIONE DELLA BIODIVERSITÀ
Bioagro offre una vasta gamma di starter per lavorazioni artigianali ed industriali di salumi, formaggi, prodotti da forno, vegetali fermentati e per la conservazione dei prodotti ittici. Lieviti enologici e muffe

UNA GAMMA DI FERMENTI CHE PUÒ SODDISFARE LE DIVERSE ESIGENZE DEL CLIENTE IN TERMINI DI QUALITÀ ORGANOLETTICA, DI VELOCITÀ DI ACIDIFICAZIONE
E DI SICUREZZA SANITARIA
Collaborazioni con molte tra le più importanti aziende agroalimentari italiane

Forte attenzione alle piccole produzioni locali
Colture “confezionate su misura” in esclusiva per i propri clienti
COLTURE STARTER PER PRODOTTI DI ALTA QUALITÀ
BIOAGRO S.r.l.
INNOVAZIONI E BIOTECNOLOGIE AGROALIMENTARI
Thiene - Tel. 0445.380793 - bioagro@bioagro.it
Consulenza tecnica nella scelta delle soluzioni produttive migliori




Direttore Responsabile
Giorgio Albonetti
Direttore Scientifico
Massimo Artorige Giubilesi
Comitato tecnico scientifico
Giancarlo Belluzzi, Vincenzo Bozzetti, Francesco Fiorente, Gaetano Forte, Luciano Negri, Erasmo Neviani, Serena Pironi, Daniele Roseghini
Coordinamento editoriale Chiara Scelsi c.scelsi@lswr.it Cel. 3490099322
Redazione Diletta Gaggia d.gaggia@lswr.it redazione.food@quine.it
Produzione Antonio Iovene a.iovene@lswr.it Cel. 3491811231
Direttore Commerciale
Costantino Cialfi c.cialfi@lswr.it tel. 3466705086
Traffico Ornella Foletti ornella.foletti@quine.it Cel. 3427968897
ABBONAMENTI www.quine.it abbonamenti.quine@lswr.it Tel. 02 864105 www.alimentinews.it
Costo copia singola: € 2,80
Abbonamento annuale Italia: € 40
Stampa
Aziende Grafiche Printing Srl Peschiera Borromeo (MI)
ABBIAMO PARLATO DI
ALITEST pag. 71
www.alitest.it
ANTARES VISION GROUP pag. 58
www.antaresvisiongroup.com
BORIN pag. 23
www.borinsrl.it
CSB-SYSTEM pag. 70
www.csb.com
DANFOSS pag. 24
www.danfoss.it
EMERSON pag. 26
www.emerson.com
GENERON SPA pag. 25
www.generon.it
NSK Italia S.p.A. pag. 24
www.nskeurope.it
RELICYC pag. 24
www.relicyc.com
SEE pag. 26
www.sealedair.com
TELEDYNE FLIR pag. 27
www.teledyneflir.com
VIDA Srl – AYAMA Software pag. 59
www.ayamaquality.it
Quine Srl
Produzione & Igiene Alimenti - Bimestrale

Rivista ufficiale del Consiglio dell’Ordine Nazionale dei Tecnologi Alimentari Autorizzazione del Tribunale di Milano n. 510 del 29-10-1983 Iscrizione al ROC n. 23531 dal 6 Maggio 2013
Tutti gli articoli pubblicati su Produzione & Igiene Alimenti sono redatti sotto la responsabilità degli Autori. La pubblicazione o la ristampa degli articoli deve essere autorizzata per iscritto dall’Editore. Ai sensi dell’art. 13 del Regolamento Europeo per la Protezione dei Dati Personali 679/2016 di seguito GDPR, i dati di tutti i lettori saranno trattati sia manualmente, sia con strumenti informatici e saranno utilizzati per l’invio di questa e di altre pubblicazioni e di materiale informativo e promozionale. Le modalità di trattamento saranno conformi a quanto previsto dal GDPR. I dati potranno essere comunicati a soggetti con i quali Quine Srl intrattiene rapporti contrattuali necessari per l’invio delle copie della rivista. Il titolare del trattamento dei dati è Quine Srl, Via Spadolini 7 - 20141, Milano, al quale il lettore si potrà rivolgere per chiedere l’aggiornamento, l’integrazione, la cancellazione e ogni altra operazione di cui all’art. 7 D.Lgs. 196/03.
INSERZIONISTI
ALITEST II Copertina
ANTARES VISION GROUP pag. 57
BIOAGRO pag. 3
CIP pag. 5
CSB-SYSTEM pag. 15
GREEN POINT pag. 13
ORMA pag. 69
VEGA III Copertina
IV Copertina
Organizzato
da

SAVE THE DATE
26-28 settembre 2023


La seconda edizione del convengo digitale di Scienza e Tecnologia Alimentare

I NUOVI VESTITI DEL CIBO: IL PACKAGING ALIMENTARE
Un antico proverbio recita “l’abito non fa il monaco”, ma quando parliamo di cibo e del “vestito” che lo avvolge, ovvero del suo imballo, possiamo dire che una simile affermazione, non è del tutto corretta.
Di fatto, l’uomo da sempre ha dovuto “confezionare” in qualche modo gli alimenti e diverse forme rudimentali di imballaggio si utilizzavano già dall’antichità.
La storia del packaging alimentare è piuttosto lunga e articolata e ha visto la sua trasformazione da un bene unicamente strutturale e strettamente necessario, in un oggetto evoluto in grado di comunicare ed entrare in relazione con il cliente fornendogli tutte le informazioni relative al prodotto e non solo, diventando in qualche caso, ai giorni nostri, anche interattivo.
Il “cibo confezionato” ha segnato la transizione definitiva dal prodotto artigianale a quello industriale, contribuendo all’estensione della shelflife degli alimenti e rendendo accessibili anche i prodotti non disponibili nelle immediate vicinanze del consumo.
Più precisamente dovremmo parlare di “cibo condizionato”, anziché confezionato, in quanto il condizionamento è parte integrante di qualsiasi processo produttivo alimentare e talvolta diventa l’elemento chiave che consente una migliore distribuzione degli alimenti, prolungandone la shelf life o garantendo a parità di conservabilità il mantenimento di livelli qualitativi superiori.

L’uso dei materiali ecosostenibili nel packaging per l’industria alimentare rappresenta una delle sfide più importanti
E se per i lunghi secoli gli strumenti e gli oggetti che si utilizzavano per il contenimento degli alimenti sono rimasti quasi uguali per forma e materiale, i nuovi modi di “vestire il cibo” sono fioriti a pari passo con lo sviluppo industriale, consentendo uno sviluppo enorme delle varietà di confezioni unito a un differente utilizzo di questi nella quotidianità.
Indubbiamente, la prima star moderna del packaging alimentare è stata la scatola metallica, a cura del francese Nicolas Appert e dell’inglese Bryan Donkin che, all’inizio dell’Ottocento scoprirono il metodo giusto proprio per sterilizzare le scatole metalliche di carne e tonno da destinare alla conservazione prolungata dei cibi.
Nel 1855 fu inventato l’apriscatole e nel 1866 le scatole furono dotate di chiave, passi fondamentali per lo sviluppo del prodotto esportato e per l’utilizzo di “alimenti non deperibili” durante le guerre.
Il cibo in scatola ha rappresentato un semplice e pratico “abito” senza tanti fronzoli che ha rivoluzionato e ha cambiato per sempre il nostro rapporto con il cibo in relazione ai due tra i più importanti fattori che determinano le sue qualità, ovvero la stagionalità e la deperibilità, racchiudendo concetti fondamentali di fruibilità e di sicurezza.
Se le conserve hanno avuto il loro impiego massivo durante le guerre (e le operazioni umanitarie), a causa dello sviluppo economico accelerato e delle conseguenti esigenze della globalizzazione del secolo scorso, l’industria del confezionamento alimentare ha perseguito nella ricerca di soluzioni di packaging innovative, che ben presto hanno scoperto le potenzialità della comunicazione veicolata tramite gli ingegnosi strumenti del design.
Uno dei primi e simbolici esempi in questo senso è il doppio imballaggio dei dadi da brodo a base di carne concentrata comparso alla fine degli anni ’40, con l’ideazione di una confezione interna in cartoncino e un packaging esterno in carta e alluminio.
Da allora le cose sono cambiate tantissimo e oggi buona parte dei cibi confezionati sono avvolti in più materiali o in materiali multi-
strato che devono sostenere la sinergia con il sistema di condizionamento utilizzato, quale ad esempio flowpack, termoretraibile, sottovuoto, atmosfera protettive, skin packaging. Arriviamo così a uno dei quesiti, secondo me più importanti, che sono alla base delle molteplici problematiche sul packaging alimentare che, per la dimensione del suo impatto ambientale, si trova attualmente ai primi posti della classifica dei settori più inquinanti. I numeri posizionano il settore dell’imballaggio in Italia come rappresentante del 2% del PIL e il 3,4% del fatturato dell’industria manifatturiera, tenendo conto che la più grossa fetta di questi numeri riguarda il settore food che da sempre è il maggior consumatore di packaging.
Secondo l’Istituto Italiano Imballaggi, i materiali prodotti in Italia nel 2021 hanno raggiunto le 18.189 tonnellate; il fatturato ha superato i 34,7 miliardi di euro (+4,4%) e anche il commercio estero risulta in crescita rispetto all’anno precedente, con un ritmo più frizzante delle importazioni rispetto a quello delle esportazioni: le prime chiudono con un +11,3%, le seconde con un +4,8%.
Come accusato principale e nemico numero uno delle politiche green e di sostenibilità intorno ai quali ormai gira tutto, la plastica è incoronata al primo posto.
Secondo il report “Unwrapped” curato da Zero Waste Europe, la domanda di plastica in Europa ha raggiunto i 49 milioni di tonnellate annue, di cui il 40% utilizzate per il packaging, quasi tutto monouso.
Si stima che il 95% del valore del packaging vada perduto dopo il primo utilizzo e le Nazioni Unite hanno calcolato che il costo globale in termini di capitale naturale per la plastica nell’industria alimentare si aggiri intorno ai 15 miliardi di euro l’anno.
Nello stesso tempo c’è da dire però che grazie allo sviluppo delle moderne tecnologie di packaging alimentare, che ahimè fanno largo uso di materiali di plastica, stiamo assistendo a un notevole ridimensionamento degli sprechi alimentari, in quanto in questo modo si ottengono migliori risultati in termini di prolungamento e sicurezza della shelf life dei cibi.
Nonostante il fatto che esistano ormai diverse tecnologie con materiali che non prevedono o riducono sensibilmente l’utilizzo di polimeri quali polietilene PE, polistirene PS, polietilentereftalato PET, polipropilene PP, attualmente la quasi totalità di alimenti freschi molto deperibili (carne, pesce, salumi, formaggi, prodotti gastronomici, ortaggi e frutta di IV gamma) è confezionata in imballaggi o vaschette di plastica, in quanto essa rappresenta la miglior modalità tecnologica per conservare in sicurezza e a un costo ragionevole i cibi.
Va ricordato il costo delle tecnologie e dei materiali innovativi ecosostenibili, ancora troppo alto per essere sostenuto dai produttori, costretti ad affrontare e combattere l’oscillazione dei prezzi, i costi energetici e quelli delle materie prime che segnano aumenti record.
L’uso dei materiali ecosostenibili nel packaging alimentare rappresenta una delle sfide importanti per l’industria alimentare, che deve bilanciare la necessità di conservare in modo efficace gli alimenti, garantire la sicu-
o i composti antimicrobici per prolungare la shelf life degli alimenti o mantenerne più a lungo la freschezza, ma è importante assicurarsi che queste sostanze non siano dannose per la salute umana.
Non possiamo altresì trascurare i segnali d’allarme che richiamano l’attenzione sulla sostenibilità delle tecnologie stesse e dei processi impiegati e necessari per produrre imballaggi che si, diventano ecologici, ma le risorse impiegate per la loro realizzazione possono produrre effetti negativi di gran lunga superiori per l’ambiente.
In questo senso il quadro della situazione diventa ancora più complesso se consideriamo il fatto che il cosiddetto effetto matrioska del “food over packaging” rimane un fenomeno largamente diffuso e criticato, ma se vogliamo essere intellettualmente onesti, dobbiamo ammettere che questo approccio è intrinsecamente collegato e funzionale all’intera “food supply chain”, dalla produzione al trasporto sino alla vendita e consumo del prodotto.
rezza alimentare e nello stesso tempo tenere conto dell’impatto ambientale.
Ad esempio, gli imballaggi biodegradabili sono compostabili e possono essere disintegrati in un breve periodo di tempo, tuttavia la loro efficacia nella conservazione può essere limitata, poiché il materiale potrebbe degradarsi troppo velocemente.
Gli imballaggi riciclabili, d’altra parte, possono essere smaltiti nel sistema di riciclaggio esistente e utilizzati per produrre nuovi imballaggi o altri prodotti, ma la loro efficienza nella conservazione degli alimenti dipende dal tipo di materiale utilizzato.
Inoltre, gli imballaggi attivi possono contenere sostanze come l’ossigeno assorbente
Ovviamente ciò non significa che dobbiamo arrenderci davanti alle problematiche attuali: le tendenze recenti indicano che è possibile utilizzare le risorse in modo ancor più efficiente traendone notevoli benefici economici, ambientali e sociali.
Gli obiettivi stringenti e giuridicamente vincolanti della legislazione europea in termini di packaging alimentare che partono dai regolamenti sui MOCA e dell’etichettatura ambientale sino alla recente proposta di modifica della direttiva 2008/98/CE relativa ai rifiuti e della direttiva 94/62/CE sugli imballaggi e i rifiuti di imballaggio offrono gli strumenti di base per lo sviluppo e l’applicazione di nuove tecnologie e metodi di packaging alimentare e maggiore efficienza nell’utilizzo delle risorse.
Grazie allo sviluppo delle moderne tecnologie di packaging
ridimensionamento degli sprechi alimentari stiamo assistendo a un notevoleBenedetta Bottari Professore Associato Microbiologia degli Alimenti Università degli Studi di Parma

IL FUTURO DEL SETTORE CARNE PASSA (ANCHE) DA QUI
Èiniziato lo scorso settembre il progetto europeo InnoMeatEdu (Acronimo della versione inglese “Strumenti digitali innovativi applicati all’istruzione superiore sostenibile in materia di scienza e tecnologia della carne: un collegamento tra industria e università”, https://innomeatedu.com/).

Il progetto riguarda lo sviluppo di materiale educativo, digitale e innovativo rivolto a studenti e professionisti del settore, sulla base di specifiche esigenze di formazione (abilità/competenze), relativamente alle scienze e tecnologie della carne, emerse dalla valutazione dei curricula esistenti nelle università dei paesi coinvolti e dal parere dei professionisti del settore, raccolto tramite questionari.
Sulla base di tali esigenze i 7 partner coinvolti, l’Università di León (Spagna), l’Università della Tessaglia (Grecia), l’Università degli Studi di Parma (Italia), l’Università di Warmia-Mazuri (Polonia), l’Instituto Politécnico de Bragança (Portogallo), il Centro Tecnológico de la Carne (Spagna) e 4Obs, società di consulenza e comunicazione (Grecia), defi-
niranno quindi i contenuti del corso di formazione che sarà sviluppato e reso disponibile online. Il materiale digitale sarà infatti liberamente consultabile tramite un Massive Open Online Course (MOOC), accessibile attraverso una piattaforma interattiva sviluppata nell’ambito del progetto. Su tale piattaforma sarà possibile iscriversi, seguire il corso e interagire attraverso un forum con la rete di esperti accademici e industriali. InnoMeatEdu infatti mira a sfruttare il potenziale del capitale umano e sociale proveniente sia dagli istituti di istruzione superiore che dall’industria del settore carneo dei Paesi europei partners del progetto, al fine di scambiare e trasferire conoscenze e know-how, con la creazione e lo sviluppo di una rete che offrirà opportunità di cooperazione tra le parti interessate, sarà foriera di innovazione e promuoverà l’occupabilità e lo sviluppo socio-educativo e personale nel settore della carne. Un settore che rappresenta un importante componente del sistema alimentare mondiale ed è in costante cambiamento, spinto in particolar modo da nuove tendenze di consumo e dalla necessità di integrarsi con la sostenibilità in ogni sua declinazione. I futuri professionisti di tale settore dovranno avere le conoscenze e le competenze necessarie per affrontare questi cambiamenti, permettendo alle aziende di rispondere prontamente alle richieste del mercato. Produzione e lavorazione delle carni, sicurezza, qualità, imprenditorialità e sostenibilità nel settore carneo saranno i pilastri portanti di questo progetto, che catalizzerà in uno strumento di grande rilievo per chi deve specializzarsi nell’ambito delle carni e dei prodotti da esse ottenuti, gli input di chi in questo settore lavora e opera con esperienza e di chi è coinvolto in attività di ricerca e formazione nell’ambito delle scienze e tecnologie della carne. E che si parli di prodotti della tradizione, come la Cecina de León (Figura 1, durante una visita aziendale nel corso della prima riunione di progetto) o di alternative innovative come gli insetti o la carne sintetica, InnoMeatEdu permetterà di formare figure in grado di leggere e correggere il futuro aziendale.
Produzione e lavorazione delle carni, e sostenibilità sono i pilastri di InnoMeatEdu sicurezza, qualità, imprenditorialitàVisita di gruppo
La Federazione Italiana si appresta a inviare un esposto formale in merito alla incompatibilità con il diritto comunitario della normativa sull’etichettatura di vini e spiriti proposta dall’Irlanda
Tutto nasce dalla decisione del Governo irlandese di inserire degli “avvertimenti sanitari”, gli “health warning”, sulle etichette di tutte le bevande alcoliche vendute nel Paese, come comunicato alla World Trade Organization (Wto), a cui ha inviato la bozza di regolamento “ai sensi dell’articolo 12 dell’Ireland’s Public Health (Alcohol)
Act 2018. Sulle bottiglie dovranno quindi apparire avvisi che metteranno in guardia dal consumo di alcool come causa di malattie, senza nessuna distinzione tra abuso e consumo responsabile.

Il reclamo di Federvini, la Federazione Italiana Industriali Produttori, Esportato-
ri e Importatori di Vini, Acquaviti, Liquori, Sciroppi, Aceti e affini, in linea con le valutazioni presentate dalle associazioni europee del comparto – Comité Vins e spiritsEUROPE – esprime l’incompatibilità delle norme irlandesi con l’attuale disciplina unionale in materia di presentazione e di corretta informazione al consumatore. In aggiunta la Federazione sottolinea che le misure irlandesi rappresentano un impedimento sproporzionato e ingiustificato alla libera circolazione delle merci all’interno del territorio comunitario, in aperto contrasto alle disposizioni degli articoli 34 e 36 del Trattato sul funzionamento dell’Unione europea. Una minaccia al mercato unico determinata da una scelta unilaterale dell’Irlanda che rischia di creare un ostacolo commerciale. (Fonte: AlimentiNews)

In linea con i principi del nuovo Piano d’azione per l’economia circolare del Green Deal europeo, il modello italiano di gestione degli imballaggi e dei rifiuti di imballaggi in alluminio rappresenta un’eccellenza nel panorama europeo. È quanto emerge dai risultati dell’assemblea annuale di CIAL-Consorzio Nazionale Imballaggi Alluminio, tenutasi lo scorso 12 maggio a Milano.
Nel 2022 è stato avviato a riciclo il 73,6% degli imballaggi in alluminio immessi sul mercato (ovvero 60.200 tonnellate) e, con il recupero energetico, il totale di quelli complessivamente recuperati cresce e si avvicina al 78%. Il tasso di riciclo degli imballaggi in alluminio in Italia ha quindi già superato abbondantemente gli obiettivi al 2025 (50%) e al 2030 (60%).
Numeri importanti che hanno consentito
di evitare emissioni serra pari a 423mila tonnellate di CO2 e di risparmiare energia per oltre 185mila tonnellate equivalenti di petrolio.
La scelta dei criteri di gestione della filiera del packaging in alluminio garantisce un rapporto costo-risultato tra i più efficienti d’Europa, realizzando un eccellente modello di sostenibilità sociale, economica e ambientale accanto a una relazione estremamente costruttiva con il territorio, grazie all’azione combinata di istituzioni, imprese, operatori, cittadini e comuni.
L’efficienza e l’efficacia del sistema italiano di raccolta differenziata e riciclo è ancor più evidente se consideriamo lo spaccato del tasso di riciclo per le lattine in alluminio per bevande che per il 2022 è pari al 91,6%, in linea con quello dei pa-
(Fonte: AlimentiNews)
NEL 2022 CRESCE LA PRODUZIONE DI PACKAGING IN VETRO



La produzione di bottiglie è aumentata dell’1,5% immettendo sul mercato oltre 2 miliardi di “pezzi”, e quella di vasetti del 2,5%. Ma per riportare il settore sulla strada della normalità ci sono ancora alcuni fattori critici: la volatilità dei prezzi energetici e l’aumento del prezzo del rottame a livelli mai raggiunti in precedenza, passando da circa 25 Euro/ton a 200 Euro/ ton. Questo aumento, oltre a incidere sul costo dei contenitori (esso rappresenta, nella media circa la metà delle materie prime usate per la produzione di vetro e 1/3 del costo di produzione), pone un rischio in termini di mantenimento degli obiettivi di riciclo e di circolarità del settore: il costo di utilizzo del rottame ha ormai superato, infatti, quello della materia prima.

I consumatori e il vetro
Per le sue caratteristiche di sicurezza alimentare, sostenibilità e riciclabilità, il vetro oggi è un materiale che guarda al futuro per 8 consumatori europei su 10 (Fonte: Indagine InSites 2022). Nel 2021 il riuso ha interessato 186.000 tonnellate di contenitori in vetro. In fatto di riciclo il vetro resta un’eccellenza italiana, il riciclo dei rifiuti di imballaggi in vetro provenienti dalle raccolte differenziate ha raggiunto 2,2 Mt e ha un tasso di riciclo pari al 76,6%, al di sopra del target europeo del 75% al 2030. L’industria del vetro si è impegnata ad arrivare al 90% nel 2030. Per questi motivi è stato l’unico materiale da imballaggio ad aver registrato in Europa negli ultimi tre anni una crescita
media dell’8% rispetto agli altri materiali da imballaggio, che hanno invece risentito di un calo tra il 24 e il 41%.
L’industria italiana del vetro cavo in cifre

Il fatturato è valutato in 2,5 miliardi di euro l’anno. Nel 2022 l’import di bottiglie e vasi è aumentato dell’11,3% e l’export è diminuito del 4,4%. Per far fronte alla domanda di contenitori è stato previsto un investimento di 400 milioni per 5 nuovi forni di fusione da realizzare entro il 2024 che garantiranno un incremento della capacità produttiva del 12%; tre di questi entreranno in funzione già nelle prossime settimane.
(Fonte: assovetro.it)

Secondo una ricerca UIF con AstraRicerche in occasione della Giornata Mondiale dell’Ambiente i giovani considerano la sostenibilità uno dei principali driver nelle loro scelte di acquisto, anche per questo, consumano prodotti plant-based oltre 2-3 volte a settimana.
È quanto emerge da un’analisi fatta per conto del Gruppo Prodotti a base vegetale di Unione Italiana Food, la più grande Associazione di rappresentanza diretta di categorie merceologiche nel settore alimentare in Italia e in Europa, in occasione della Giornata Mondiale dell’Ambiente del 5 giugno. Secondo la ricerca condotta da UIF con AstraRicerche , il 75% degli under 35 sceglie abitualmente prodotti a base vegetale e li considera sostenibili. Per il 65%, inoltre, i plant-based rappresentano

un fenomeno ben radicato nelle proprie abitudini alimentari e non una semplice “moda” passeggera.
“A tavola i plant-based possono aiutare a seguire una dieta sostenibile”, dichiara Salvatore Castiglione, Presidente Gruppo Prodotti a base vegetale di Unione Italiana Food. “Circa 1 italiano su 2 (47%) afferma di sapere che questi prodotti hanno un’im-
do alimentare e il 46% aggiunge che richiedono un minore impiego di risorse naturali - come suolo, acqua ed energia - rispetto ad altri alimenti. Gli alimenti a base vegetale non solo offrono una scelta ecologicamente responsabile al consumatore, ma sono anche riconosciuti dagli italiani come una soluzione concreta per ridurre l’impatto ambientale legato al consumo (e alla
Le recenti tecniche innovative della coltura cellulare, dell’ingegneria tissutale e della fermentazione di precisione sono alla base di nuovi, potenziali alimenti come la carne ottenuta da cellule coltivate o le proteine del latte ottenute da microrganismi.

L’EFSA al fine di prendere atto di tutti i più recenti sviluppi scientifici connessi alla valutazione del rischio per poter definire gli standard su cui valutare la sicurezza di queste nuove tecnologie alimentari ha raccolto opinioni e spunti di riflessione da parte di personalità scientifiche, rappresentanti di agenzie europee, internazionali e nazionali, aziende tecnologiche e operatori del settore alimentare, senza dimenticare anche gruppi di consumatori. Ramiro Alberio, professore di biologia dello sviluppo presso l’Università di Nottingham nel Regno Unito, sul tema ha spiegato: “L’ingegneria cellulare e tissuta-
scolo o da altro organo, queste possono essere coltivate in condizioni controllate senza le altre parti dell’organo. L’ingegneria cellulare viene già utilizzata in medicina per rigenerare tessuti o sostituire cellule danneggiate o malate. Le tecnologie sono ormai avanzate e potrebbero essere applicate in altri settori come quello agro-
alimentare. La cosiddetta fermentazione za microrganismi per produrre prodotti specifici come proteine, oligosaccaridi del latte identici a quelli del latte umano, vitamine oppure fibre”.
È compito dell’EFSA valutare la sicurezza dei nuovi alimenti nell’UE, compresi quelli derivati tramite nuove tecnologie come la coltura cellulare e l’ingegneria tissutale. (Fonte: efsa.europa.eu)
ALL’ASSEMBLEA MONDIALE DELLA SALUTE FOCUS SULL’ARRICCHIMENTO DEGLI ALIMENTI
Le carenze di micronutrienti e l’Arricchimento su Larga Scala degli Alimenti (LSFF) al centro di un evento collaterale alla 76ª Assemblea Mondiale della Salute (WHA) a Ginevra.

La metà di tutti i bambini in età prescolare e i due terzi di tutte le donne in età fertile nel mondo soffrono di almeno una carenza di micronutrienti, fenomeno noto anche come “fame nascosta”. Queste carenze causano una serie di problemi di salute, dal deterioramento dello sviluppo cognitivo nei bambini all’aumento del rischio di infezioni e condizioni come anemia e cecità.
L’arricchimento degli alimenti è stato identificato come una strategia economicamente conveniente e sostenibile per combattere la fame nascosta e migliorare la salute pubblica. Secondo l’OMS, l’arricchimento degli alimenti di base può migliorare lo stato dei micronutrienti nelle popolazioni e ridurre l’incidenza delle malattie associate, in particolare nei paesi a basso e medio reddito dove l’accesso a diete e integratori diversificati è limitato. Sono ben ottantaquattro i Paesi che potrebbero beneficiare dell’istituzione di nuovi programmi obbligatori di arricchimento.
La proposta di risoluzione della WHA ha unito i settori della politica sanitaria, dei diritti delle persone con disabilità e della nutrizione. Oltre 70 organizzazioni globali, regionali e nazionali hanno sottoscritto la risoluzione e stanno lavorando attivamente per supportarne l’approvazione. (Fonte: AlimentiNews)
mio ERP.
Così ho tutto sotto controllo.
Efficienza, trasparenza, flessibilità – questo è ciò che conta ora. L’IT è la chiave per ottenerlo. Che si tratti di ERP, MES, rintracciabilità o software per la pianificazione intelligente: il CSB-System è la soluzione completa per le aziende del settore alimentare. Così già oggi potete ottimizzare la vostra produzione e domani digitalizzerete l’intera azienda.
Per saperne di più sulle nostre soluzioni per il settore alimentare: www.csb.com

Il
a cura della Redazione
DOI: 10.1016/j.ecolind.2022.108781
Verso un’economia circolare nel settore agroalimentare: valutazione dell’impronta idrica delle perdite alimentari nelle filiere ortofrutticole italiane


Towards circular economy in the agrifood sector: Water footprint assessment of food loss in the Italian fruit and vegetable supply chains. Ecological Indicators, Volume 137, Aprile 2022
GP. Agnusdei, B. Coluccia, AM. Pacifico, PP. Miglietta
Negli ultimi anni, il settore agroalimentare è stato fortemente influenzato dalla carenza di risorse, dalla perdita di cibo e dagli sprechi lungo l’intera catena di approvvigionamento. Questo studio valuta, in una prospettiva di ciclo di vita, l’impronta idrica delle perdite di frutta e verdura che si verificano all’interno della filiera agroalimentare italiana, analizzando i potenziali legami tra le politiche di economia circolare e la gestione dell’acqua.
La metodologia di studio si compone di tre fasi consequenziali: la definizione dei confini del sistema, la raccolta dei dati da database e report e l’elaborazione di tali dati. Sulla base dei dati disponibili sulle perdite alimentari, sono stati scelti per l’analisi i seguenti alimenti, che rappresentano cir-

ca il 60% dell’offerta nazionale di frutta e verdura italiana: pomodori e cipolle per il macrogruppo degli ortaggi; aranci, limoni, mele e uva per il macrogruppo dei frutti.
Valutando l’impronta idrica per le sei categorie di prodotti, questo studio ha rilevato che, sebbene inferiore ad altri prodotti, la quantità di uva persa lungo la filiera determina un’altissima percentuale di perdita idrica. La filiera del pomodoro si è rivelata la più sostenibile in termini di perdita idrica, a causa della scarsa quantità di acqua necessaria per coltivare il pomodoro. L’analisi del mercato italiano dell’interscambio ortofrutticolo ha evidenziato che le perdite idriche sono dovute principalmente alle importazioni da Francia e Spagna, in linea con gli elevati volumi di scambio. Infine, è stata osservata una debolezza della filiera ortofrutticola italiana durante il trasporto, perché, in questa fase, grandi quantità di perdite alimentari si associano a grandi volumi di perdite idriche. Lungi dall’essere l’unico strumento da utilizzare nei processi decisionali, la valutazione della perdita idrica incorporata nella perdita alimentare, però, può essere utile per gestire i processi di filiera degli alimenti deperibili, garantendo miglioramenti della resa del processo, tracciabilità della qualità alimentare e mitigazione dell’impatto ambientale.
DOI: 10.1016/j.scitotenv.2022.158365
Gli impatti ambientali della diversa gestione del riso biologico in Italia considerando diversi scenari produttivi The environmental impacts of different organic rice management in Italy considering different productive scenarios. Science of The Total Environment, Volume 853, 20 Dicembre 2022
V. Vaglia, J. Bacenetti, F. Orlando, S. Alali, E. Bosso, S. BocchiDa un lato, la coltivazione del riso ha un ruolo chiave nella sicurezza alimentare mondiale; dall’altro, ha un elevato potenziale impatto sull’ambiente e sulla salute umana, dovuto principalmente all’uso estensivo di pesticidi e alle emissioni di gas serra causate dalle coltivazioni allagate. In Italia, il settore del riso si basa principalmente su monocolture ad alto input. La transizione verso l’agricoltura biologica può migliorare le prestazioni ambientali della coltivazione del riso secondo l’attuale strategia europea di pro-
duzione alimentare sostenibile. Attraverso la metodologia LCA, lo studio mira a valutare la variabilità degli impatti ambientali e il potenziale di mitigazione di quattro strategie di gestione adatte alla produzione di riso biologico nel Nord Italia e due livelli di potenziale produttivo osservati durante il monitoraggio triennale su 10 aziende agricole nell’area di studio. I risultati suggeriscono un notevole potenziale della produzione di riso biologico per mitigare l’impatto sulle risorse naturali, a seconda delle pratiche agricole scelte.
La grande differenza degli impatti sui cambiamenti climatici è dovuta alla variabilità esistente in termini di resa e di modelli disponibili di pratiche agricole.
Oggi gli agricoltori potrebbero raggiungere valori di resa accettabili, grazie a una gestione più efficiente rispetto al passato (es. fertilità del suolo basata sulla fertilità biologica e sui componenti stabili dell’humus; diminuzione della pressione delle infestanti attraverso la graduale introduzione di altre colture in rotazione).

DOI: 10.1016/j.afres.2022.100199
L’influenza della formulazione e del materiale di confezionamento sulle proprietà reologiche del cioccolato al latte

The influence of formulation and packaging material on the rheological properties of milk chocolate. Applied Food Research, Volume 2, uscita 2, Dicembre 2022
A. Barros Verde, I. Dutra Alvim, V. Luccas, L. Marangoni Júnior, RM. Vercelino Alves
La fibra è un sostituto dello zucchero nei cioccolatini, ma ne cambia l’igroscopicità e le caratteristiche reologiche se il loro imballaggio non ne evita l’aumento di umidità. L’obiettivo di questo studio è stato quello di valutare la permeabilità al
vapore acqueo di diversi materiali di imballaggio (BOPP/metBOPP (polipropilene orientato biassiale/metallizzato) BOPP/ BOPP bianco e cellophane) e l’effetto della permeabilità sulle proprietà reologiche (secondo il modello di Casson) di tre tipi di cioccolato al latte: standard, con l’aggiunta di inulina e frutto-oligosaccaridi durante la conservazione a 20°C/75% UR. A causa dell’elevata igroscopicità delle fibre, il contenuto di umidità iniziale dei cioccolati con fibre era superiore a quello del cioccolato standard. I risultati hanno indicato che i cioccolatini con fibre dovrebbero essere confezionati in materiali con barriera media o alta al vapore acqueo, come BOPP/metBOPP e BOPP/BOPP, per evitare cambiamenti reologici durante la conservazione.
DOI: 10.1016/j.foodchem.2022.134522
Nuova applicazione della spettroscopia 1H NMR unita alla chemiometria per l’autenticazione del cioccolato fondente Novel application of 1H NMR spectroscopy coupled with chemometrics for the authentication of dark chocolate. Food Chemistry, Volume 404, Parte A, 15 Marzo 2023
E. Truzzi, L. Marchetti, A. Fratagnoli, MC. Rossi, D. Bertelli
L’applicabilità della spettroscopia 1H NMR unita alla chemiometria per il controllo della qualità del cioccolato fondente è stata studiata per la prima volta per rilevare gli equivalenti di burro di cacao (CBE) al di sopra del limite consentito dalla normativa europea. Miscele di grassi di cioccolato con CBE nell’intervallo 0-50% sono state preparate e analizzate mediante spettro-

scopia 1H NMR. Set di dati composti da aree di picchi o variabili spettrali (impronte digitali) nella regione del glicerolo sono stati testati per la creazione di modelli statistici multivariati. Sono stati utilizzati metodi di analisi discriminante dei minimi quadrati parziali (PLS-DA) e di regressione (PLS-R) per identificare correttamente il tipo di CBE e quantificarne rispettivamente la concentrazione. Le prestazioni dei modelli creati sui due dataset sono state valutate e confrontate in termini di indicatori chemiometrici. La robustezza dei modelli è stata studiata attraverso l’analisi di set di test e test di permutazione casuale. I modelli di rilevamento delle impronte digitali hanno rivelato risultati fruttuosi nella classificazione e nella quantificazione dei CBE nelle miscele, dimostrando l’applicabilità dell’NMR nel controllo della qualità del cioccolato.
Una rassegna sui processi a pressione verde dei succhi di frutta mediante microfluidica: qualità, sicurezza e conservazione
A review on green pressure processing of fruit juices using microfluidization: Quality, safety and preservation. Applied Food Research, Volume 2, Issue 2, dicembre 2022 SV. Singh, R. Singh, A. Singh, AV. Chinchkar, MG. Kamble, SJ. Dutta, SB. Singh
La microfluidica con omogeneizzazione ad alta pressione è un trattamento a pressione relativamente nuovo, emergente e verde nella produzione di succhi di frutta, che ne induce un cambiamento nelle proprietà e nella sicurezza microbiologica dovuta allo stress meccanico. L’omogeneizzazione ad alta pressione è stata recentemente utilizzata in diversi studi sulla lavorazione dei succhi di frutta per ottenere l’inattivazione microbica (sicurezza alimentare), l’inattivazione di enzimi

naturalmente esistenti (enzimi ossidativi) e altri cambiamenti fisico-chimici desiderabili (qualità). A causa della pressione, la quantità dell’attività enzimatica può essere modulata in termini di inattivazione o attivazione di enzimi deterioranti (fenolasi). Questa recensione si concentra sulla descrizione dell’effetto del microfluidizzatore su vari sistemi enzimatici presenti nei succhi come la polifenolossidasi (PPO), la perossidasi (POD), la pectina metilesterasi (PME) e le proprietà fisico-chimiche, tra cui la distribuzione delle dimensioni delle particelle, la stabilità di sedimentazione, la composizione nutrizionale, l’inattivazione microbica. La microfluidica è un concetto innovativo che migliora la qualità fisicochimica dei succhi di frutta, aumentandone la stabilità riducendo la granulometria e la torbidità, aiutando nell’estrazione di composti bioattivi dai tessuti nei succhi, inattivando microrganismo ed enzimi. In conclusione, l’HPH potrebbe essere una potenziale alternativa per migliorare la durata di conservazione dei succhi di frutta.
DOI: 10.1016/j.foodcont.2022.109331
Effetto del congelamento super raffreddato sulla qualità della carne di filetto di maiale in diverse condizioni di scongelamento
Effect of supercooled freezing on the quality of pork tenderloin meat under different thawing conditions. Food Control, Volume 144, Febbraio 2023

RL. Poudyal, R. Maekawa, MA. Redo, R. Khanal, T. Suzuki, M. Watanabe
Questo studio ha esaminato l’influenza del congelamento dopo il super raffreddamento, che gli autori hanno chiamato congelamento super raffreddato, sulla qualità della carne di filetto di maiale. Sono stati condotti esperimenti per il congelamento lento e rapido con e senza sottoraffreddamento. La formazione dei cristalli di ghiaccio è stata esaminata mediante tomografia computerizzata a raggi X e microscopio ottico. Successivamente, i campioni sono stati scongelati per con-
tribuire a uno studio olistico sulla qualità della carne suina prima dell’ulteriore lavorazione o consumo. I metodi di scongelamento studiati includono l’uso di acqua di rubinetto, frigorifero, aria ambiente e acqua ghiacciata. Dopo lo scongelamento sono state impiegate misurazioni della qualità, come la perdita di gocciolamento, la consistenza e l’impedenza. I risultati hanno mostrato che le condizioni di congelamento rapido e lento sottoraffreddamento hanno prodotto cristalli di ghiaccio più piccoli e distribuiti in modo omogeneo rispetto al congelamento convenzionale senza sottoraffreddamento. Il metodo di scongelamento ha un’influenza sostanziale sulla perdita di liquidi e sull’impedenza elettrica alle alte frequenze. Il congelamento rapido sottoraffreddamento combinato con lo scongelamento frigorifero è risultato essere il metodo migliore per conservare la qualità della carne, grazie alla morfologia dei cristalli di ghiaccio e al migliore riassorbimento dell’acqua durante lo scongelamento.


VICENZI DOLCEZZA SOSTENIBILE
GRUPPO STORICO DELL’INDUSTRIA DOLCIARIA ITALIANA, VICENZI È MOLTO ATTIVO NON SOLO CON NUOVI PRODOTTI, MA ANCHE CON INNOVAZIONI TECNOLOGICHE
E IMPIANTISTICHE, SPESSO IMPRONTATE ALLA SALVAGUARDIA AMBIENTALE
La storia del Gruppo Vicenzi è iniziata nel 1905 con Matilde Vicenzi che avvia una piccola bottega di pane, pasticceria e alimentari a San Giovanni Lupatoto Verona, dove si trova ancora oggi la sede principale dell’azienda, e che rappresenta uno dei primi esempi di imprenditoria al femminile.
L’espansione dall’attività artigianale alla piccola industria arriva a partire dalla metà del 1900, quando Giuseppe Vicenzi, Presidente del Gruppo e nipote del fondatore, ha voluto ricreare l’attività artigianale di Matilde su larga scala. Tra gli anni Sessanta e Settanta viene industrializzata una produzione che fino ad allora era stata artigianale, con la realizzazione del nuovo stabilimento a San Giovanni Lupatoto. La scelta di specializzarsi in particolare nella produzione dell’amaretto e, successivamente, del savoiardo ha portato l’azienda negli ultimi anni a consolidare il proprio marchio sul mercato estero. Il Gruppo Vicenzi, come lo
conosciamo oggi, nasce nel 2005, quando Giuseppe acquisisce l’intero settore della pasticceria Parmalat, con i due marchi Grisbì e Mr. Day. Oggi Vicenzi è conosciuta in oltre 110 paesi. L’azienda ha un fatturato di 146 milioni euro: 107 milioni in Italia e 39 milioni dall’estero. I dipendenti sono circa 360, suddivisi nei tre stabilimenti di San Giovanni (VR), Bovolone (VR) e Nusco (AV).
Simona Marolla, Export Marketing Manager del Gruppo Vicenzi ci parla delle novità del Gruppo non solo in termini di prodotti, ma anche di tecnologie e di iniziative a favore della sostenibilità ambientale.

Dott.ssa Marolla, quali sono i prodotti più rappresentativi dell’azienda?
I prodotti più storici e rappresentativi della tradizione di Matilde Vicenzi sono i Savoiardi Vicenzovo, gli Amaretti e le Sfoglie. Quest’ultima famiglia, in particolare, rappresenta il simbolo della tra-
dizione pasticcera di Matilde Vicenzi e comprende un’ampia varietà di prodotti creati ancora oggi secondo la ricetta originaria che prevede la realizzazione di 192 sottili e croccanti strati di finissima pasta sfoglia alternati con il burro. A fianco dei prodotti storici si sono affiancate nel tempo una serie di altre referenze,
Simona Marolla, Export Marketing Manager del Gruppo VicenziNel 1905 Matilde Vicenzi avvia
una piccola bottega di pane, pasticceria e alimentari a San Giovanni Lupatoto

soprattutto a partire dal 2005 quando l’azienda ha iniziato a produrre i prodotti Grisbì e Mr. Day. Tra le novità più significative sicuramente ricordiamo la creazione della gamma di referenze senza glutine e lattosio, che ha permesso a consumatori con intolleranze di poter apprezzare alcuni dei prodotti più amati di Vicenzi: Millefoglie, Vicenzovo, Amaretto morbido e Grisbì. Per quanto riguarda il mercato estero, in particolare, ogni anno nascono nuove confezioni in latta, legate anche alle festività dei diversi paesi, che all’interno presentano varie combinazioni di prodotti di sfoglia e di frolla. Sempre per l’estero di recente sono nati due nuovi prodotti, ispirati alla storia del tipico soft baked cookie americano.
Il mercato americano è, infatti, molto rilevante per l’export del Gruppo. Esatto. La filiale commerciale statunitense Vicenzi USA INC. si trova a Miami, e rappresenta un esempio di crescita globale. Oggi, la consapevolezza dei consu-

matori statunitensi sulla sostenibilità è ai massimi livelli e le aspettative circa le pratiche di sostenibilità dei produttori alimentari sono notevoli. Ricoprono grande importanza la selezione delle materie pri-
me, il valore nutritivo e la qualità dei prodotti, l’innovazione dei processi produttivi e il loro impatto sull’ambiente, nonché la tutela della sicurezza dei lavoratori e dello spirito di comunità. Oltre che sulla
scelta di materie prime di qualità, il Gruppo si è focalizzato su prodotti speciali allineati con le richieste del mercato americano prestando attenzione alle allergie e inclusione di opzioni etniche e religiose. Ingredienti naturali e non-OGM, assenza di conservanti, coloranti, utilizzo di olio


di palma certificato, uova da allevamento a terra in alcuni prodotti, Certificazione Kosher dell’Orthodox Union, prodotti senza glutine e senza lattosio. La predisposizione di Vicenzi USA INC. verso la sostenibilità si è realizzata anche nella ricerca di nuove soluzioni di packaging
con l’obiettivo di privilegiare l’utilizzo anche di materiali riciclati e riciclabili (principalmente cartone e plastica) e la riduzione della grammatura degli imballi per i prodotti finiti. Inoltre dal 2019 Vicenzi USA INC. è membro del The Sustainability Consortium (TSC), un’organizzazione no-profit globale che supporta le aziende nel percorso di cambiamento verso lo sviluppo di prodotti sempre più sostenibili. Un esempio di sostenibilità lungo la catena di fornitura dei prodotti di Vicenzi USA INC. si realizza nelle reti di collaborazione con alcuni dei principali rivenditori quali Walmart o Ahold-Delhaize con i quali Vicenzi USA INC. si impegna a fornire prodotti che rispettano requisiti selettivi di sostenibilità per la creazione di cooperazioni commerciali.
Tornando al mercato italiano, oltre a nuovi prodotti, ci sono innovazioni tecnologiche e impiantistiche recenti?
Certamente. Nel corso del 2022 è stato installato un nuovo impianto di processo per l’impasto del Savoiardo, prodotto storico dell’azienda, al fine di monitorare e meglio gestire il controllo delle variabili di processo (portata, temperatura, pressione) e il dosaggio delle materie prime che costituiscono l’impasto che viene poi colato sulle teglie, nonché la gestione dell’aria per l’emulsione del prodotto. In ambito di confezionamento, è stata rivista tutta l’impiantistica del confezionamento secondario del savoiardo, dalla creazione del flowpack multipacco all’inscatolamento, con la creazione di una nuova scatola (wrap around) che permette di unificare tutti i formati del prodotto (200-300-400 grammi) e che è anche shelf ready, cioè funge direttamente da espositore sul punto vendita. Questa soluzione, permettendo di disporre più chili di prodotto e di avere una saturazione migliore del bancale e riducendo il numero di tipologie di referenze, consente di ottimizzare i flussi in entrata e in uscita dallo stabilimento. Sempre in ambito di confe-
zionamento Savoiardo, è stata introdotta una nuova tipologia di confezionatrice che ha permesso di produrre per la prima volta in azienda una scatola di cartone da 5 Kg, con all’interno il prodotto accomodato e non alla rinfusa.
Il Gruppo Vicenzi è molto attivo sul fronte della salvaguardia ambientale. Quali sono le iniziative intraprese per la riduzione dell’impatto ambientale dei prodotti e dei processi produttivi in azienda?
Il Gruppo Vicenzi ha mantenuto un forte orientamento all’innovazione nel campo della progettazione e selezione degli imballaggi, in modo tale da ridurre gli impatti ambientali secondo principi guida consolidati nel tempo rappresentati dall’utilizzo, dove possibile, di materiali riciclati, dall’adozione di monomateriali con maggiore riciclabilità (es. riduzione di poliaccoppiati), dalla riduzione di over-packaging e conseguente riduzione dei consumi di materie prime. Ne è un esempio concreto il cartone unificato wrap around, che riducendo il numero complessivo delle tratte (navettaggio) in entrata e uscita dallo stabilimento, ha comportato una riduzione dell’inquinamento ambientale. Tale scatola, inoltre, richiede per essere realizzata una sensibile riduzione di energia, rispetto alla scatola precedente. Il passaggio alla stampa FollowMe in azienda, inoltre, ha semplificato il flusso di lavoro riducendo al minimo lo spreco di stampe e aumentando la produttività degli utenti. La nuova gestione delle stampanti assicura, infatti, agli utenti di stampare solo i contenuti necessari, prevenendo stampe non necessarie e quindi sprechi. Inoltre, aiuta a proteggere la riservatezza dei documenti, che non vengono stampati fino a quando l’utente non è presente presso il dispositivo di stampa.
Una parte fondamentale della gestione della sostenibilità del Gruppo Vicenzi riguarda l’implementazione di processi e soluzioni finalizzate a incrementare l’efficienza produttiva e a ridurre gli impatti ambientali e
gli sprechi, come la misurazione e valutazione degli aspetti energetici, in termini di consumi di energia elettrica e gas naturale, tramite l’analisi dell’uso della risorsa idrica, delle acque reflue e della produzione di rifiuti. Negli ultimi anni sono stati sviluppati specifici progetti per il miglioramento delle performance energetiche nei diversi stabilimenti, come l’installazione di caldaie ad alto rendimento, di nuovi CIP per il lavaggio con regolazione dei consumi per acqua calda, di sistemi robotizzati per automatizzare i processi, garantendo uno standard igienico e qualitativo con performance elevate anche dal punto di vista energetico, nonché il rinnovamento di impianti con riduzione indiretta dei consumi. Nel 2022 è stata avviata, in uno dei nostri stabilimenti, una campagna di misurazione sulle tubazioni dei macchinari delle perdite d’aria compressa, con conseguente sostituzione delle parti non funzionanti; questo ha permesso un risparmio di energia elettrica e, di conseguenza, di avere un miglior impatto sull’ambiente. L’analisi è stata accompagnata anche dalla riduzione della potenza complessiva del parco compressori aria al fine di ridurre le perdite a vuoto dell’impianto.
L’utilizzo di energie alternative e la riduzione degli impatti legati alla logistica sono temi attuali per le aziende alimentari italiane. Quali sono le soluzioni adottate da Vicenzi?

Presso lo stabilimento di San Giovanni Lupatoto è presente un impianto fotovoltaico per la produzione di energia elettrica da fonti rinnovabili. La gestione della risorsa idrica è un altro aspetto rilevante della salvaguardia ambientale e il monitoraggio periodico dei consumi idrici permette di identificare le criticità e delineare gli interventi di miglioramento. Il Gruppo Vicenzi implementa costantemente le attività finalizzate alla riduzione degli impatti legati alla gestione della logistica, sia per quanto riguarda la distribuzione dei prodotti finiti in Italia e all’estero, grazie alla scelta dei fornitori, applicando criteri di sostenibilità identificati nel contesto del Progetto Rating trasportatori con l’Osservatorio T.C.R e tramite il monitoraggio delle emissioni di CO2 legate alle attività di trasporto.
Ultimo aspetto, ma non meno importante, è la selezione delle materie prime con caratteristiche ben definite a livello di sostenibilità e/o provenienza. Quali sono le scelte di Vicenzi?
Buona parte delle uova utilizzate nei prodotti Vicenzi sono di origine italiana e provenienti da allevamenti a terra. La maggior parte del cacao impiegato dal Gruppo Vicenzi è caratterizzato dalla certificazione UTZ Rain Forest Alliance che garantisce la provenienza e l’applicazione di programmi di agricoltura sostenibile.
a cura della Redazione

PALLET SOSTENIBILE E TRACCIABILE PER IL SETTORE DELLE CARNI
Il ciclo virtuoso gestito da Relicyc in maniera diretta, dal recupero del prodotto alla sua reintroduzione nel mercato, permette di garantire una serie di plus, tra cui sostenibilità, tracciabilità e qualità. Il modello adottato nasce da un’esigenza di attenzione verso l’ambiente che mira a riutilizzare le risorse a fine vita e indirizzarle correttamente al riciclo.
I pallet in plastica proposti da Relicyc vantano una serie di accorgimenti produttivi che li rendono ideali nel settore alimentare e, in particolare, nell’ambito della lavorazione delle carni, in quanto sono progettati per avere tutte le caratteristiche tecniche perfette per salvaguardare la merce e per garantire performance elevate.

Questi imballaggi, ad esempio, sono estremamente igienici: non assorbono liquidi né odori, non sono attaccabili da muffe, sono facilmente lavabili (possono essere puliti anche con un getto d’acqua) e la manutenzione è ridotta rispetto ai pallet in legno.
La plastica, inoltre, non produce schegge e segatura, che possono inquinare la merce, i locali di lavorazione e i mezzi di trasporto dedicati. Ma c’è anche un altro aspetto importante che rende questi prodotti adatti a chi lavora nell’ambito della macelleria, ovvero la possibilità di essere impiegati in cella frigorifera.
Il peso rispetto al pallet in legno è molto contenuto e per gli operatori risultano quindi più
I CUSCINETTI DI NSK PREVENGONO CEDIMENTI NELLE LATTINE
L’industria alimentare e delle bevande è estremamente esigente, soprattutto perché i fermi delle linee di produzione possono rivelarsi molto costosi in tutti i tipi di applicazioni. Non fa eccezione la produzione di lattine di alluminio per bibite, bevande isotoniche e alcoliche. Ripetuti cedimenti dei cuscinetti montati sul mandrino che aziona gli ugelli spruzzatori delle macchine per il rivestimento delle lattine causavano gravi interruzioni della produzione e tempi morti estremamente costosi su una linea di produzione per grandi volumi. I tecnici di NSK hanno condotto un’analisi approfondita dell’applicazione, ispezionando accuratamente i cuscinetti e il lubrificante. L’attività ha evidenziato che i cuscinetti si grippavano

a causa della fuoriuscita del grasso, espulso dall’aria ad alta pressione utilizzata nel processo produttivo. Le tenute dei cuscinetti erano inadeguate a prevenire questo effetto indesiderato.
NSK ha raccomandato l’adozione dei propri cuscinetti radiali rigidi a sfere con tenute non striscianti serie VV e geometria di gioco interno C3. Offrendo prestazioni elevate in ambienti contaminati, questa configurazione innovativa garantisce una tenuta efficace senza aumentare l’attrito o le temperature di esercizio. In particolare, il labbro non strisciante riduce la resistenza nel cuscinetto, garantendo un vantaggio importante nelle applicazioni in cui la coppia resistente è un fattore critico.
PREVENIRE GLI SPRECHI ALIMENTARI ED ENERGETICI
Fino al 10% di tutte le emissioni di gas serra sono attribuibili alla perdita e allo spreco di cibo. Grazie a soluzioni di refrigerazione efficienti dal punto di vista energetico, i supermercati possono raffreddare il cibo esattamente quanto basta per evitare che gli alimenti si deteriorino, il tutto risparmiando sull’energia complessivamente consumata. Per molti anni,
il settore del food retail ha seguito un percorso di trasformazione sostenibile, a partire dalla transizione verso l’utilizzo di gas come la CO2 e altri refrigeranti a basso GWP. La digitalizzazione fa parte della fase successiva di questo percorso.

Il Gruppo Salling e Danfoss A/S hanno annunciato una collaborazione con Microsoft per supportare la sostenibilità
maneggevoli; sono nestabili, con un rapporto fino a 1 a 3 rispetto al legno, permettendo di abbattere lo spazio di stoccaggio; essendo resistenti all’umidità, mantengono anche una tara costante.
RELICYC www.relicyc.com
La soluzione di NSK ha garantito un’eccellente ritenzione del grasso, consentendo al tempo stesso all’aria compressa ad alta pressione di fluire attraverso il cuscinetto, come richiesto dalle procedure operative dell’impianto.
NSK Italia www.nskeurope.it


TAPPETO PER LA SANIFICAZIONE DI SUOLE E DI RUOTE DI CARRELLI
Borin presenta Wave, il tappeto per locali interni specifico per la spazzolatura e la sanificazione di suole e di ruote di carrelli, soluzione per lo standard di certificazione BRCGS versione 9 del punto 4.6.6. Wave certifica il 99,94% di abbattimento della carica batterica. La disposizione a onda delle setole garantisce il massimo dell’igiene, indirizzando lo sporco in fessure di raccolta, grazie alle quali è possibile valutarne lo stato di pulizia.





Grazie alle due chiavi di estrazione e alla struttura completamente sezionabile, i componenti vengono rimossi in sicurezza per agevolare la pulizia.
Il gonfiore tardivo è un problema significativo nella produzione di formaggi a pasta dura o semidura, perché contribuisce allo spreco alimentare, diminuisce l’efficienza e genera gravi perdite economiche all’industria casearia. La causa sono i clostridi butirrici; FILIDF ha confrontato i metodi di rilevazione (https://tinyurl.com/mf9kc8pa) e quantificazione di questi batteri e il sistema AMP-6000 di SY-LAB, distribuita in esclusiva in Italia da Generon SpA, risulta di gran lunga più affidabile rispetto a quelli finora utilizzati. L’analisi è miniaturizzata, automatizzabile e richiede solo due giorni contro i tradizionali sette.
del settore della distribuzione alimentare attraverso la digitalizzazione. Il Gruppo Salling mira a creare un’azienda a zero emissioni di anidride carbonica e nei prossimi anni investirà oltre 320 milioni di euro in progetti di sostenibilità energetica. Nell’ambito di questa iniziativa, ha avviato una collaborazione con Danfoss e Microsoft per sviluppare i migliori servizi
digitali per monitorare la temperatura e il consumo energetico dei sistemi di refrigerazione utilizzati nei supermercati, sfruttando una metodologia di manutenzione preventiva per evitare sprechi alimentari ed energetici.

TRASMETTITORI RADAR NON CONTATTIVI PER L’INDUSTRIA DI PROCESSO
Emerson ha presentato i trasmettitori di livello e portata radar non contattivi Rosemount™ Serie 1208 per contribuire ad aumentare l’efficienza operativa delle applicazioni delle utility che operano su acqua e acque reflue e dell’industria di processo. Le prestazioni della serie 1208 superano quelle dei dispositivi a ultrasuoni e idrostatici, fornendo misure di livello e di flusso in canale aperto affidabili e precise, consentendo alle aziende di aumentare l’efficienza delle operazioni e di raggiungere la conformità ambientale.

Gli operatori dei settori acqua e acque reflue, food and beverage, chimico e altri processi industriali spesso utilizzano dispositivi a ultrasuoni e idrostatici per le applicazioni di monitoraggio dell’acqua quando i trasmettitori radar sono considerati troppo costosi, ingombranti o complessi. Il trasmettitore Rosemount 1208 è dotato di tecnologia FMCW (Frequent Modulated Continuous Wave) a scansione rapida a 80 GHz su un singolo chip elettronico, che offre misure accurate e affi-
dabili in un dispositivo compatto ed economico, ideale per le applicazioni con vincoli di spazio o requisiti di conformità, come le applicazioni su acqua.
Grazie alla tecnologia FMCW a scansione rapida e agli algoritmi avanzati, la nuova famiglia di trasmettitori è in grado di raccogliere fino a 40 volte più informazioni rispetto ai dispositivi radar tradizionali. Queste caratteristiche garantiscono una precisione di misurazione del livello di ±2 mm (0,08’’) a una distanza di 15 m, aiutando le aziende a ottimizzare i processi e a soddisfare i requisiti ambientali. Inoltre, il design non contattivo non prevede parti in movimento o requisiti di calibrazione, creando un dispositivo praticamente privo di esigenze di manutenzione, che riduce al minimo le procedure manuali e garantisce prestazioni e affidabilità a lungo termine.
Il trasmettitore Rosemount 1208C offre opzioni di comunicazione a due fili 4-20 mA e HART®, che consentono di implementa-
PRISMIQ™, UN PORTAFOGLIO DI SOLUZIONI PER PACKAGING CONNESSO
Oggi, l’aspetto, la funzione e la sensazione tattile di una confezione possono fare la differenza nel soddisfare le aspettative del cliente. È quindi essenziale migliorare l’esperienza del consumatore, personalizzando il suo coinvolgimento tramite touch point esperienziali e interattivi e offrendo vantaggi lungo tutta la catena di approvvigionamento.
Grazie alla possibilità di scansione e connettività data dagli smartphone, si possono offrire soluzioni che vanno ben oltre il packaging. Il packaging digitale, noto anche come imballaggio intelligente, permette di collegare i prodotti fisici a dispositivi digitali per interagire direttamente con i consumatori. Inoltre consente di migliorare la comunicazione offrendo un contenuto più ampio attraverso codici stampati come QR o watermark che permettono la tracciabilità 1:1 e la corrispondenza tra i singoli prodotti e il consumatore finale.
Progetta, stampa e connetti prismiq™ è stato progettato come uno sportello unico per coloro che non solo desiderano disporre di dati facilmente accessibili per i propri clienti, ma che vogliono semplificare e collegare tutte le informazioni sui prodotti in un unico posto, oltre a progettare il packaging.
§ Servizi di progettazione: per realizzare un design creativo, compresa la prototipazione, per esplorare una serie di idee per promuovere il prodotto.
re una diagnostica avanzata. In tal modo si supporta la manutenzione predittiva e una risoluzione dei problemi più efficace, con conseguenti riduzione dei tempi di fermo e miglioramenti dell’efficienza operativa.
§ Stampa digitale: per personalizzazione dettagliata, flessibilità e facilità di realizzazione di disegni multipli per ogni tiratura di stampa, messaggi personalizzati su ogni confezione.


§ Smart Packaging: per un coinvolgimento dei consumatori e una maggior trasparenza della catena di approvvigionamento, che contribuirà all’efficienza operativa.

TRASMETTITORI RADAR NON CONTATTIVI PER L’INDUSTRIA DI PROCESSO
Nell’industria alimentare è essenziale poter controllare con attenzione la temperatura dei beni deperibili durante le varie fasi di produzione, trasporto, stoccaggio e vendita. I frequenti casi di avvelenamento causati da alimenti contaminati e preparati in modo improprio evidenziano l’esigenza di un maggior controllo dei processi produttivi. Poiché è quasi sempre coinvolto un fattore umano, le linee di preparazione degli alimenti richiedono validi strumenti per automatizzare le operazioni critiche, con l’obiettivo di minimizzare il rischio di errore umano e al tempo stesso di contenere i costi. Le termocamere sono esattamente uno strumento di questo tipo. Con le termocamere FLIR, è possibile eseguire misurazioni di temperatura automatiche e senza contatto in molte applicazioni dell’industria alimentare. Le uscite video analogiche possono essere visualizzate su monitor e i dati di temperatura digitali, comprese le uscite video MPEG4, possono essere indirizzati a un computer tramite Ethernet.
Come funziona
Gli elementi principali che eseguono le misurazioni di temperatura senza contatto nell’industria alimentare sono una termocamera e il relativo software. Questi elementi agiscono da sensori “smart” senza contatto per ispezionare il 100% del prodotto, misurando la temperatura di apparecchiature, prodotti refrigerati e alimenti cotti quando escono dal processo di cottura.
Le termocamere sono semplici da utilizzare, di ingombro ridotto e possono essere posizionate praticamente ovunque, secondo necessità. Possono anche essere impiegate per ispezionare la sigillatura della confezione e migliorare l’efficienza in altre operazioni di lavorazione degli alimenti.
Le termocamere FLIR sono dotate di firmware e interfacce di comunicazione che consentono il loro utilizzo nel controllo di processo automatizzato. Software di terze parti semplificano l’integrazione di questi strumenti in sistemi di

machine vision automatizzati, senza dover ricorrere a codice di controllo personalizzato.
La termografia per il controllo qualità e la sicurezza dei prodotti
La termografia è innanzitutto uno strumento per il controllo qualità (QA). Questa tecnologia trova un ottimo impiego nel controllo della qualità e della sicurezza dei prodotti cotti a base di carne. Una termocamera montata in modo permanente può registrare la temperatura, ad esempio, dei bocconcini di pollo all’uscita da un forno con trasportatore continuo. L’obiettivo è verificare che siano cotti al punto giusto, e non disidratati per una cottura eccessiva. Il ridotto contenuto di umidità rappresenta tra l’altro una perdita di resa in base al peso. Le termocamere possono anche essere utilizzate per l’ispezione su linee di precottura a microonde. Oltre a migliorare la qualità e la sicurezza del prodotto, è possibile aumentare la produttività complessiva. Un ulteriore vantaggio è rappresentato dalla riduzione dei costi energetici.

Monitoraggio delle attrezzature
Oltre alle ispezioni sui cibi cotti, le termocamere possono monitorare i forni a catena. Possono persino essere integrate in un circuito di feedback per contribuire a controllare la temperatura del forno.
Un altro uso delle termocamere in applicazioni per forni a catena è il monitoraggio dell’uniformità della temperatura lungo la larghezza del nastro trasportatore del forno a catena. Se un elemento riscaldante in un forno elettrico subisce un guasto o si rileva un riscaldamento non uniforme in un forno a convezione, un
lato del nastro di trasporto potrebbe essere a temperatura inferiore. Questo problema può essere rapidamente individuato grazie alle termocamere.
Simili controlli di qualità sono molto più difficili con i sensori di temperatura convenzionali a contatto. Pertanto, le termocamere possono aiutare a correggere la variabilità indesiderata e a migliorare la qualità prima di trovarsi costretti a scartare un lotto di prodotto.
Ispezioni degli imballaggi
È disponibile un software che consente alle termocamere di individuare oggetti e motivi ricorrenti nelle immagini. Un esempio di applicazione per l’identificazione di schemi ricorrenti è la produzione di pasti surgelati. Il sistema di machine vision termica può utilizzare il software di riconoscimento di modelli geometrici per verificare il corretto riempimento dei diversi vani del vassoio.
Un’ulteriore applicazione per le termocamere è il monitoraggio delle operazioni di riempimento dei contenitori. Sebbene il riempimento rappresenti raramente un problema di sicurezza del prodotto, può influire sulla resa e sulla conformità alle normative. È possibile definire diverse zone sul contenitore utilizzabili per attivare un allarme e rimuovere i contenitori riempiti in modo eccessivo o insufficiente. Le termocamere rappresentano un’alternativa migliore rispetto alle fotocamere a luce visibile quando flaconi o barattoli sono realizzati in vetro o plastica di colore scuro.
PULIZIA EFFICACE IN OGNI PUNTO
I SISTEMI CIP CONSENTONO LA CORRETTA PULIZIA DEGLI IMPIANTI, INFLUENZANDO POSITIVAMENTE LA QUALITÀ DEL PRODOTTO FINALE.
L’AZIONE MECCANICA, I PRODOTTI CHIMICI, LA TEMPERATURA E LA
DURATA DEL PROCESSO DI PULIZIA SONO I FATTORI CHE INFLUENZANO LA
BUONA RIUSCITA DEL PROCESSO DI PULIZIA
Stefania Milanello Esperta in tecnologie alimentari e divulgatrice scientifica

Cleaning In Place (CIP) è il processo di pulizia dell’interno di un macchinario di processo senza la rimozione o lo smontaggio di parti dello stesso. Si tratta quindi di sistemi chiusi per la completa pulizia di impianti, senza interventi di pulizia manuale.
Gli impianti CIP vengono utilizzati dalle aziende alimentari per la pulizia degli impianti, quali scambiatori di calore, omogeneizzatori, centrifughe, serbatoi di stoccaggio, tubazioni delle linee di produzione di bevande e alimenti, per assicurare elevati standard di igiene e pulizia, come parte integrante del processo di produzione. La corretta pulizia degli impianti influenza la qualità del prodotto finale. A seconda delle necessità, le aziende alimentari possono optare per impianti CIP manuali, semiautomatici o completamente automatizzati, grazie a PLC e pannelli comandi touch screen, che consentono la memorizzazione di diversi parametri, come il tipo di lavaggio, la temperatura, la durata, la concentrazione delle soluzioni acida/basica. Gli impianti CIP sono dotati di diversi serbatoi (detergenti acidi e alcalini, disinfettanti, acqua), pompa di mandata e ri-

LA CORRETTA PULIZIA
DEGLI IMPIANTI CONDIZIONA LA QUALITÀ DEL PRODOTTO
FINALE
presa dei lavaggi, di termostato, valvole manuali o automatiche, riscaldamento elettrico, a vapore in vasca a soluzione alcalina o con scambiatore esterno e di diversi serbatoi.

PARAMETRI CHE INFLUENZANO L’EFFICACIA DI UN SISTEMA CIP
L’efficacia di un impianto CIP dipende dall’azione meccanica, dai prodotti chimici, dalla temperatura, dalla durata del processo di pulizia. In un sistema CIP, l’azione meccanica è generata dalla pressione e dal flusso turbolento dei liquidi di pulizia che entrano nelle tubazioni a grande velocità, grazie alla presenza di ugelli ad alta pressione nei serbatoi. Per aumentare o diminuire l’azione meccanica occorre agire sulla portata e sulla pressione dei fluidi circolanti.
La tipologia e la concentrazione dei prodotti chimici utilizzati influenzano il risultato
Gli
finale. I detergenti alcalini o acidi si devono sciogliere velocemente in acqua, non devono essere schiumogeni e sono non corrosivi, devono avere un’elevata azione bagnante, emulsionante e disperdente, essere facilmente risciacquabili e possibilmente poco costosi. Se lo sporco lo consente, le aziende alimentari possono applicare lavaggi CIP monofase, ovvero utilizzare solo il detergente alcalino eliminando la fase di lavaggio con il detergente acido, con importanti risparmi di tempo, acqua ed energia, e minore corrosione delle attrezzature. Per lo sporco più tenace, come lo sporco cotto che si forma sulle superfici degli scambiatori di calore, ricco di sostanze quali proteine, grassi, zuccheri e minerali rispetto a seconda dell’alimento trattato, si opera con detergenti maggiormente concentrati, temperature più elevate e utilizzo di soluzioni detergenti alcalina e acida in sequenza. Si tratta
in questo caso di un sistema bifase, perché la detergenza avviene in due fasi distinte: alcalina e acida. In genere, vengono effettuati uno o più pre-risciacqui per evitare che lo sporco residuo si essicchi sulle pareti, viene utilizzato un detergente alcalino a caldo 60-80°C, eventualmente recuperato e riciclato, si eseguono risciacqui intermedi a temperatura ambiente con o senza recupero, si utilizza un detergente acido (50-60 °C) a cui segue un risciacquo. Il disinfettante chimico è a bassa temperatura, in genere tra i 20 e i 30°C, e va risciacquato a sua volta a temperatura ambiente.
La ricerca sui detergenti mira a trovare prodotti ad azione detergente più rapida ed efficace e che al contempo consentano di ridurre i consumi di acqua ed energia. Altre opzioni prevedono l’utilizzo di un detergente – disinfettante acido in modo da eliminare sia una detersione (quella con il prodotto al-
impianti CIP vengono utilizzati per la pulizia
di scambiatori di calore, omogeneizzatori, centrifughe, serbatoi di stoccaggio, tubazioni delle linee di produzione di bevande
calino) sia uno dei risciacqui, con risparmio di tempo, acqua ed energia.
La disinfezione può avvenire grazie alla circolazione di vapore o acqua calda o con prodotti a base di acido peracetico, disinfettanti clorati o biguanidi in caso di assenza di trattamenti termici.
Per massimizzare l’efficacia di un detergente o di un disinfettante è fondamentale che essi vengano utilizzati alla giusta temperatura. Per risparmiare sulla quantità delle soluzioni detergenti e massimizzarne l’efficacia, le temperature stanno tra 50 e 80°C. In genere, durante il ricircolo la temperatura aumenta di circa 5°C, mentre, per impedire la formazione di depositi di calcare, l’acqua ha una temperatura di 20-30°C. Infine, occorre trovare il giusto compromesso tra una pulizia efficace e il tempo del trattamento CIP. La necessità di cicli di pulizia rapidi, per limitare il tempo di fermo produzione, costringe le aziende a una valutazione scrupolosa dei restanti parametri che necessariamente impattano maggiormente sul sistema CIP. Fattore imprescindibile che impatta sui tempi di risciacquo e di lavaggio è la lunghezza del circuito.
PROGETTAZIONE
La fase di progettazione del sistema CIP è indispensabile per l’ottimizzazione di tutti i parametri precedentemente presi in considerazione al fine di raggiungere il risultato desiderato. L’azienda alimentare dovrà quindi scegliere tra un impianto centralizzato o decentrato, ovvero un’unica sezione CIP oppure sezioni più piccole in prossimità delle apparecchiature da pulire. Ciò dipende da numerosi fattori, quali la grandezza dell’impianto, la tipologia e i volumi delle apparecchiature da pulire, le problematiche gestionali e i costi delle diverse soluzioni impiantistiche. Altro fattore da considerare è il CIP a singolo uso o multi-uso. Nel primo caso, i prodotti chimici non vengono
ricircolati, recuperati e riutilizzati, nel secondo caso sì e poiché il prodotto rimesso in circolo conterrà i solidi rimossi durante il precedente processo di pulizia, occorrerà prevedere dei filtri. Inoltre il sistema a singolo uso ha dalla sua un limitato investimento iniziale, controlli semplici, bassa manutenzione e portata di sostanze chimiche e acqua per il risciacquo minore. Si adatta bene a una unità portatile collocata accanto agli impianti. Di contro le soluzioni di lavaggio non vengono recuperate, ma scaricate al trattamento acque. Sono soluzioni impiantistiche adatte in caso di sporco rilevante, che rende difficile riciclare il detergente utilizzato per un utilizzo successivo. I sistemi multiuso o a riciclo invece consentono il recupero delle soluzioni detergenti e acqua per il loro riutilizzo. Sono soluzioni valide quando una grossa quantità di sporco viene già rimossa in fase di pre-risciacquo. La soluzione detergente può essere riutilizzata, consentendo risparmi notevoli sia di acqua che di detergente. Si tratta però di soluzioni ad alto costo di investimento, complesse e che richiedono manutenzioni importanti. Tutte le fasi di riempimento, svuotamento, ricircolo e distribuzione delle soluzioni avviene in modo automatico e programmato. Qualsiasi sia la scelta dell’azienda, è fondamentale analizzare i cosiddetti punti morti, ovvero tratti di tubazioni in cui i prodotti chimici potrebbero avere difficoltà ad accedere, consentendo l’accumulo e la proliferazione dei microrganismi, fonte di contaminazione delle lavorazioni successive. La caratterizzazione di eventuali punti morti può essere effettuata grazie a studi CFD (Computational Fluid Dynamics - Fluidodinamica computazionale). Essi consentono la simulazione e l’analisi, da parte di un software di progettazione assistita da computer, del flusso di un liquido, in questo caso detergenti e sanificanti, all’interno della tubatura, di una valvola, di un raccordo etc. Un sistema CIP efficiente consente di ridurre i costi della sanificazione in modo significativo, grazie al risparmio di tempo e manodopera, al minor consumo di prodotti chimici
e di acqua, dato dal ricircolo e dal dosaggio preciso, risparmio di energia. Con un sistema CIP, la sanificazione è più efficace e costante nel tempo, grazie all’utilizzo di un processo con parametri, quali temperatura, tempi, detergenti e disinfettati, validati. Infine, ma non meno importante, i sistemi CIP liberano gli operatori da operazioni gravose e a volte pericolose, riducendo, se non azzerando, la possibilità di contatto con prodotti chimici pericolosi e temperature e pressioni elevate.
VERIFICA DELL’EFFICACIA DELLA SANIFICAZIONE
È fondamentale verificare l’efficacia della sanificazione, in modo da confermare o modificare i parametri presi in considerazione, e minimizzare le contaminazioni. Per questo le aziende alimentari si adoperano in controlli analitici al fine di rilevare eventuali livelli di contaminazione residua o la presenza di residui di sostanze organiche che provino la non completa efficacia della sanificazione. I controlli microbiologici richiedono tempi di attesa lunghi per la crescita dei microrganismi e possono essere utilizzati in fase di validazione delle operazioni di pulizia con sistemi CIP. Per una valutazione rapida si utilizzano test diagnostici rapidi basati sul dosaggio di adenosintrifosfato (ATP) o di proteine. L’ATP è presente in tutte le cellule, in quanto fornisce l’energia necessaria per le diverse attività cellulari, e viene rilevata mediante il metodo bioluminometrico, grazie a piccoli strumenti portatili. In particolare, l’enzima luciferina-luciferasi catalizza in modo specifico l’idrolisi dell’ATP. La quantità di luce prodotta da questa reazione enzimatica è direttamente proporzionale alla quantità di ATP presente nel campione ed è misurata con un bioluminometro. Il ritrovamento di ATP sulle superfici indica quindi la presenza di sporco. È un metodo rapido, che non sostituisce la ricerca microbica tradizionale, ma è di facile esecuzione e rapido. Eventuali proteine residue possono essere rilevate con metodi colorimetrici. Le proteine reagiscono con un reagente presente nel kit sviluppando un colore confrontabile con una scala di riferimento.
 Vincenzo Bozzetti
Vincenzo Bozzetti

SCIENZA E CONOSCENZA PER UNA SOSTENIBILITÀ REALE
PRODUZIONE ALIMENTARE E SOSTENIBILITÀ: LE SOLE SOLUZIONI CREDIBILI POGGIANO
LE LORO RADICI NELL’EQUILIBRIO COMPLESSIVO DELL’ECOSISTEMA.
Il professor Erasmo Neviani, dopo la laurea in Scienze delle Preparazioni Alimentari presso la Facoltà di Agraria dell’Università di Milano nel 1980, ha trascorso un interessante periodo di studi in Francia, presso il Laboratoire de Biochimie et Technologie Laitières dell’INRA di Jouy-en-Josas (Francia). Nel 1985 entrò nel mondo del latte, come Sperimentatore della Sezione di Microbiologia ed Enzimologia dell’Istituto Sperimentale Lattiero Caseario di Lodi (del MAF), diventando Direttore di Sezione a dicembre del 1999. Nel 2002 fu nominato Professore Ordinario di Microbiologia Agraria presso la Facoltà di Agraria dell’Università di Parma
e, dal 2009 al 2012 diventò Preside della Facoltà. Nel triennio 2013-2015 venne eletto Presidente di SIMTREA - Società Italiana Microbiologia Agro-Alimentare e Ambientale. Attualmente ricopre il ruolo di Presidente del Comitato Italiano della FIL-IDF. Il professor Erasmo Neviani ha pubblicato oltre 300 lavori di carattere scientifico, a cui si aggiungono 7 libri. È stato a lungo collaboratore di differenti riviste del settore a carattere divulgativo. I principali argomenti delle sue ricerche riguardano la microbiologia e tecnologia del latte e dei suoi derivati. Però i suoi studi e approfondimenti spaziano nell’intero arco della microbiologia degli alimenti.

Alcuni mesi fa l’umanità ha tagliato il traguardo volante degli 8 miliardi di abitanti nel nostro pianeta. Quali riflessioni possono emergere in relazione alla disponibilità di alimenti e agli effetti sugli ecosistemi agricoli?
La storia della vita dell’uomo sul pianeta si intreccia con l’evoluzione dei sistemi agricoli e di produzione del cibo. Insediamenti urbani e migrazioni umane sono fenomeni sociali spesso riconducibili in primo luogo alle caratteristiche agricole dei territori, alla disponibilità di acqua e, in ultima analisi, alla possibilità di produrre e/o disporre di cibo. L’evoluzione delle conoscenze dell’uomo sul come sfruttare i territori per produrre alimenti e le attività industriali per la loro trasformazione rese necessarie dall’aumento della domanda di una popolazione in continua crescita hanno quindi, inevitabilmente, comportato effetti sull’ambiente.
Gli Uomini però non sono i soli ad abitare il pianeta Terra…
Volendo semplificare, gli esseri umani sono parte integrante di complessi ecosistemi ambientali, composti da esseri viventi (animali,
vegetali, insetti, microrganismi) e da componenti “inanimati” del territorio. Le modalità impiegate per le produzioni agricole e zootecniche e la definizione dei modelli di produzione e di consumo degli alimenti non possono che influenzare l’ecosistema nel suo insieme. Si tratta di sistemi caratterizzati da equilibri delicati la cui modificazione può comportare, alternativamente, la modificazione del sistema, la sua evoluzione o la sua scomparsa. La capacità di evolvere rispondendo alle pressioni e alle modificazioni del contorno definisce la resilienza dell’ecosistema. Il mantenimento delle interazioni e degli equilibri all’interno dell’ecosistema è pertanto essenziale per la sua sopravvivenza ed evoluzione. Gli esseri umani sono solo una parte di questo complesso sistema e la nostra attività dovrebbe pertanto salvaguardare gli equilibri che regolano la sopravvivenza degli ambienti che ci ospitano.
Tra le produzioni sostenibili e le differenze geografiche si possono trovare nuovi equilibri? L’esposizione universale di Milano 2015 aveva portato al centro dell’interesse mondiale il problema di come produrre alimenti e nutrire l’Uomo, nel rispetto della Terra sulla quale viviamo e dalla quale attingiamo risorse esauribili. Un tema che nel suo complesso
doveva, e deve, considerare un network di tematiche interconnesse quali la salvaguardia dell’ambiente e del suolo, la disponibilità di acqua potabile, la qualità della produzione di alimenti, il benessere animale, le possibili innovazioni e la riduzione degli sprechi nella filiera agro-alimentare. Tematiche da definire nel complesso alla luce dei nuovi scenari globali, diversificati nelle regioni del mondo, al centro dei quali rimane il tema del diritto al cibo e a una alimentazione sana e sicura per tutti gli abitanti del pianeta. La presenza di grandi zone geografiche del pianeta dove il tema del diritto al cibo non riesce a trovare risposte adeguate lo rende sicuramente un argomento prioritario. Occorre trovare soluzioni diversificate in grado, nel loro insieme, di soddisfare i differenti bisogni locali di cibo sicuro. La carenza di fonti alimentari potrebbe inoltre comportare, come in passato, lo spostamento di popolazioni alla ricerca di luoghi per vivere meno ostili. Gli aspetti sociali collegati a questi fenomeni sono difficili da prevedere e potenzialmente molto complessi da risolvere. La quantità di popolazione malnutrita nel mondo impone di pensare a come ottenere una più corretta distribuzione delle risorse alimentari e della disponibilità di acqua potabile.

trasformazione degli alimenti hanno inevitabilmente comportato effetti sull’ambiente
Le attività industriali per laAbbiamo parlato di sostenibilità con Erasmo Neviani.
Diritto al cibo, salute e sostenibilità, inevitabili connessioni?
È noto che sul pianeta sono presenti circa un miliardo di persone sottonutrite, al contempo, si osserva un continuo incremento di malattie legate, in qualche modo, all’eccessivo o scorretto consumo di cibo. L’obesità, ad esempio, riguarda molti milioni di persone, non solo nei paesi ricchi, ed è in costante crescita. I problemi di salute correlati alla scorretta alimentazione incidono enormemente anche sull’economia dei differenti paesi; sia in termini di assistenza sanitaria per patologie correlate, che di perdita di produttività. L’aumento della popolazione del pianeta, concentrato in larga parte in Paesi già a elevata densità demografica, è solitamente accompagnato da un aumento più che proporzionale della domanda di proteine, soprattutto di origine animale, grassi e carboidrati la cui produzione può generare problemi di sostenibilità, legate sia al maggiore consumo di terra coltivabile che di impatto dell’intensificazione produttiva sull’inquinamento ambientale.
Quali gli effetti dei cambiamenti climatici?
Parallelamente l’aumento della frequenza di eventi climatici estremi e le variazioni del trend delle precipitazioni, rischiano di incidere sulle rese delle colture e sulla produzione globale. Alcuni scenari sfavorevoli, ma non irrealistici, ipotizzano che in conse-
guenza dei cambiamenti climatici due terzi del mondo potrebbero andare incontro a carenza di approvvigionamento idrico.
Perché è importante ridurre gli sprechi?
Grandi quantità di cibo vengono scartate lungo la filiera produttiva o sprecate nelle nostre case, e diventano un rifiuto, evidenziando un grave problema di efficienza. In uno scenario globale anche ridurre lo spreco dovrebbe essere una necessità. Ma come operare a questo fine non è sicuramente banale da definire. Il recupero non è sempre semplice da organizzare e ha costi differenti in relazione alle caratteristiche dei territori e all’organizzazione sociale delle popolazioni che li abitano. Se il recupero degli scarti diventa troppo costoso e non competitivo diviene difficile da sostenere.
Nella comunicazione di massa non manca la soluzione unica, cosa pensa al riguardo? Differenti le sfide e i rischi che limitano la capacità di espandere in modo sostenibile il sistema agro-alimentare globale, differenti devono essere le risposte! La capacità di vincere tali sfide e soddisfare le aspettative alimentari delle popolazioni future dipende fortemente dall’impiego corretto dei progressi della scienza e dell’innovazione tecnologica che ne potrebbe conseguire. Impiego che nel suo complesso non può non tenere in considerazione la necessità
di non perturbare gli equilibri necessari alla sopravvivenza dell’ecosistema. Le possibili soluzioni, per essere credibili, devono trovare differenti declinazioni in relazione alle caratteristiche e all’organizzazione sociale delle diverse popolazioni e Paesi del pianeta, consentendo comunque la crescita ai Paesi oggi poveri. Approcci parziali e intransigenti che non tengono conto della precarietà e della debolezza di questi equilibri possono essere fonte di gravi problemi. Produzione, trasformazione, distribuzione, conservazione e l’eventuale riciclo degli alimenti comportano problematiche tecnologiche, logistiche ed energetiche che implicano costi differenti in relazione alle peculiarità locali. Pertanto, non sempre si possono trovare soluzioni univoche valide per tutti i territori. Si tratta di trovare dei modelli di sviluppo idonei per un sistema diversificato e caratteristico per regioni geografiche e popolazioni differenti.
Invero non sono poche le ancore delle “convinzioni antiche” legate al passato… È evidente che i modelli attuali di produzione e consumo degli alimenti spesso non sono compatibili con la sostenibilità attuale e futura. Non è più possibile rimanere ancorati al passato. È un lusso che nessuno si può permettere. In particolare nei paesi in via di sviluppo, ma sempre con maggiore urgenza anche nel cosiddetto mondo industrializza-

Si osserva un continuo incremento di malattie legate all’eccessivo o scorretto consumo di nutrienti
to. Alcune nuove e apparentemente accattivanti proposte, quali il biologico, il “green” o il “Km zero”, devono essere correttamente declinate alla luce della globalità della popolazione mondiale per non risultare “insostenibili” lussi delle fasce più fortunate delle popolazioni e delle zone ricche del pianeta. L’obiettivo di rendere disponibile cibo a tutti in misura adeguata a una corretta nutrizione, nel contesto di una popolazione in crescita, rende obbligatorie nuove scelte.
Professor Neviani, cosa pensa della soluzione vegetariana o vegana?
È evidente che il consumo di alimenti di origine animale non riesce a sostenere il ritmo della crescita demografica e quindi il suo peso nella dieta delle popolazioni dei Paesi ricchi debba essere ridotto o comunque rivolto a fonti proteiche più efficienti. Anche gli effetti sull’ambiente di scelte di diete vegetariane e/o vegane, indipendentemente dal rigoroso rispetto dei convincimenti etici personali di chi le adotta, dovrebbero essere valutate nel lungo periodo in relazione al loro potenziale impatto ambientale.
Probabilmente gli atteggiamenti intransigenti e univoci non rappresentano soluzioni sostenibili per tutti i luoghi del pianeta. Si deve trovare il modo di incrementare le produzioni in maniera “equilibrata”, o meglio, nel rispetto degli equilibri che caratterizzano gli ecosistemi che ci ospitano. Sprechi, efficienza, sostenibilità, disponibilità, impatto ambientale sono temi collegati che chiedono quindi soluzioni integrate valide anche per il futuro.
Un futuro imminente, se non erro?
Questa sfida non è più rinviabile. In sintesi, si deve considerare la necessità di intensificare la produzione di alimenti, nuovi o tradizionali, definendo modelli di produzione rispettosi della sostenibilità. Dobbiamo produrre di più e meglio, per dare cibo sicuro e sano a tutti, ma con modalità che non esauriscano le fonti naturali di approvvigionamento e non danneggino il nostro ecosistema.
Veniamo ora alla frontiera avanzata dei “nuovi alimenti”, come li considera?
La produzione di “nuovi alimenti” grazie allo sviluppo delle tecnologie alimentari potrebbe essere parte della soluzione. Ovviamente non si tratta di tradire e abbandonare le eccellenze dei vari territori (alimenti DOP e IGP), che anzi in questo contesto devono essere tutelate e valorizzate, ma di offrire a quella parte del mondo che non ha o non può permettersi le eccellenze anche soluzioni alternative. All’orizzonte si affacciano al contempo le produzioni di alimenti “sintetici”, prodotti per sintesi di laboratorio e/o con l’impiego di tecniche di organismi geneticamente modificati. In molti casi si tratta non solo di ipotesi ma di concrete possibilità, alcune di prossima probabile applicazione. Se questi cibi, che per semplicità definiamo “sintetici”, saranno valutati sicuri e più sostenibili rispetto alle produzioni alimentari tradizionali potranno anche rappresentare una parte importante degli scenari futuri di sviluppo. Per il momento si tratta di ipotesi che necessitano di verifiche che dovranno comunque tenere in considerazione, anche in questo caso, l’impatto sul lungo periodo sull’ecosistema (ecosistemi) e sul suo equilibrio duraturo.
In buona sostanza l’arrivo del “nuovo” è sempre stato ostacolato non crede?
In molte parti del nostro pianeta la percezione del consumatore riguardo l’innovazione ne ostacola la diffusione. Nonostante lo sviluppo e la globalizzazione richiedano tecnologie innovative per poter affrontare sfide sempre nuove, spesso l’innovazione viene osteggiata e respinta da una buona parte dei consumatori occidentali che la
percepisce come artificiale e pericolosa. Molto spesso, queste impressioni non sono basate su opinioni razionali, ma sono frutto di sensazioni emozionali, frequentemente influenzate dai media.
In questo contesto che ruolo assume la tutela del consumatore?
Il diritto del consumatore di disporre di informazioni corrette e complete diventa in questi scenari sinonimo di diritto non solo di accedere al cibo, ma anche di scegliere consapevolmente come nutrirsi e che parte dedicare del proprio portafoglio a tali scelte.
Tutto questo riporta al tema iniziale della capacità di rispettare gli equilibri complessivi che mantengono in vita il nostro ecosistema, o almeno l’ecosistema che conosciamo e del quale siamo parte?
In effetti altri equilibri anche estremi per la sopravvivenza dell’ecosistema sono possibili ma non è detto che ci comprendano o che siano favorevoli alla componente che gli esseri umani rappresentano. Solo l’impiego intelligente del sapere e della tecnologia può permetterci di trovare le soluzioni opportune.
In conclusione, scienza e conoscenza sono indispensabili per la sostenibilità del pianeta? Certamente! La necessità di un approfondimento scientifico, di condivisione delle conoscenze e di innovazione tecnologica. Queste le sole chiavi per uno sviluppo sostenibile del sistema alimentare in equilibrio con l’ecosistema complessivo che ci comprende.
Grazie professor Neviani!alimentari delle popolazioni future dipende dall’impiego corretto dell’innovazione tecnologica
La capacità di soddisfare le aspettative
Elaborazione dati Cerved Marketing Intelligence a cura di David Migliori

PRODOTTI DOLCI E SALATI, OBIETTIVO INNOVAZIONE COSTANTE
Un 2023 positivo, con molte luci e poche ombre, per il settore dei prodotti da forno e della pasticceria industriale. Cerved conferma che la crescita per il variegato mondo che spazia dai grissini e le fette biscottate ai tanti dolci da ricorrenza resta solida; il comparto continua a guardare con attenzione al di fuori dei confini nazionali con solidi risultati frutto del buon lavoro di posizionamento fatto dalle nostre aziende e dalla buona reputazione che ci viene riconosciuta internazionalmente. Il mercato interno registra un incremento a valore, un dato che si spiega principalmente con gli aumenti dei prezzi; tuttavia, nel medio periodo i consumi dovrebbero tornare a crescere.
I DATI E LE PROSPETTIVE
Le previsioni di Cerved, rese note da uno studio pubblicato a marzo 2023, stimano un fatturato complessivo del settore che raggiungerà la notevole cifra di 7.120 milioni di euro, mostrando una solida crescita del 5%. Vero trascinatore di questa crescita sarà l’export, con le vendite sui mercati esteri che, nonostante un previsto rallentamento rispetto al biennio 2021/2022, continueranno a segnare andamenti positivi sia in termini di valore che di volume. Le esportazioni rappresenteranno quasi la metà della produzione complessiva a valore, un chiaro segno della fiducia e dell’apprezzamento che il prodotto italiano gode all’estero, grazie agli elevati stan-
dard qualitativi delle nostre aziende. Le importazioni, che rappresentano il 14% dei consumi, registrano una dinamica di prezzi in crescita.
A livello interno, il mercato nazionale è stimato sui 4.685 milioni di euro e mostrerà un incremento a valore superiore al 4%. Questo aumento, tuttavia, è interamente attribuibile all’aumento dei prezzi dei prodotti finiti, che continueranno ad aumentare anche nel 2023.
La domanda interna, che dovrebbe subire una leggera contrazione di circa il 2% in termini reali, dovrebbe riprendere nel medio termine, dopo un triennio negativo, grazie a una futura normalizzazione dei consumi e da un previsto calo dei prezzi dei prodotti finiti.
IMPORT ED EXPORT
I principali Paesi da cui importiamo sono la Germania, che rappresenta il 28,2% del totale, seguita dalla Francia con il 17% e dall’Austria con il 14%. Seguono la Spagna che contribuisce al 10,4% delle importazioni, il Belgio col 9% e la Polonia l’8%. Degna di nota è l’incremento significativo delle importazioni dalla Cina, che pur pesando ancora meno dell’1%, ha registrato un aumento del 56,9% rispetto all’anno precedente. Tra i paesi con una quota di import già importante, si segnalano in grande crescita Belgio e Polonia. La Francia è il principale paese di destinazione dell’export, con una quota del 14,9%. Seguono la Germania al 13,5% e gli Stati Uniti al 10,4%. Altri importanti mercati di destinazione includono il Regno Unito con il 6,9%, la Spagna con il 5,4% e la Svizzera con il 3,1%. Tra i paesi di destinazione dei nostri prodotti, la Polonia ha registrato una crescita significativa del 41,4% rispet-
to all’anno precedente, gli Stati Uniti del 29% e Israele del 29,2%. La Russia, non stupisce, resta l’eccezione, unico paese a segnalare una netta marcata diminuzione della quota di esportazioni.
LA RIPARTIZIONE PER SEGMENTI
Interessante a questo punto approfondire la dimensione e l’andamento della produ-
zione per singoli segmenti, considerandoli separatamente (vedi Tabella 2). Nel segmento del pane industriale e sostitutivi del pane (includendo anche l’importante comparto delle fette biscottate), la produzione rappresentava il 28,7% nel 2019 e ha registrato un aumento leggero nel corso degli anni, arrivando al 29,5% nel 2020, poi dimi -

nuendo leggermente al 29,1% nel 2021 e al 28,9% nel 2022.
La biscotteria e pasticceria industriale ha rappresentato il 36,7% della produzione nel 2019, con un aumento costante fino al 37,4% nel 2020. Tuttavia, ha subito una diminuzione nel 2021, scendendo al 35,9%, ma è risalita al 36,1% nel 2022. Nel segmento delle merendine e torte pronte, la produzione era del 20% nel 2019, con una leggera diminuzione nel corso degli anni, arrivando al 19,8% nel 2020 e al 19,9% sia nel 2021 che nel 2022. Infine, i prodotti da ricorrenza hanno rappresentato il 14,6% della produzione nel 2019, con una diminuzione nel 2020 al 13,3%. Tuttavia, sono aumentati al 15,1% nel 2021 e si sono stabilizzati al 15% nel 2022.
DUE GRANDI E TANTI MEDIO PICCOLI
A dominare il mercato sono i due grandi marchi storici nazionali, Ferrero e Barilla, ma la presenza di numerosi segmenti e nicchie di mercato riduce il livello di concentrazione; il fatto che sia possibile operare anche con ridotte possibilità di fare investimenti e di know-how, consente anche a piccole e piccolissime imprese di avere una presenza competitiva. Si tratta spesso di aziende, anche di dimensioni molto piccole,
con caratteristiche quasi artigianali e con diffusione esclusivamente a livello locale. Le imprese operative nella produzione di prodotti di panetteria freschi (ATECO 10.71.1) sono poco meno di 27.000, mentre quelle attive nella produzione di fette biscottate, biscotti e prodotti di pasticceria conservati (ATECO 10.72) sono poco meno di 1.800. Quasi il 50% delle aziende di ambedue gli ambiti sono ditte individuali, di solito imprese a conduzione familiare mentre le società di capitali pesano per circa 1/3 delle aziende.
DIVERSITÀ REGIONALI
Le aziende produttrici di pane industriale si concentrano nelle regioni settentrionali e sono condizionate dalla diversa propensione al consumo di pane fresco nelle diverse aree geografiche. Infatti, nel centro-sud si concentrano prevalentemente panificatori artigianali. Le aziende produttrici di biscotti e pasticceria industriale sono per il 70% concentrate al Nord in particolare in Piemonte, Lombardia e Veneto.
Le aziende produttrici di sostitutivi del pane sono concentrate per il 50% nell’Italia nord-occidentale, per il 25% nell’Italia nord-orientale, per il restante 25% nel
Centro e per la parte restante nel Sud e nelle isole.
Una caratterizzazione più marcatamente regionale contraddistingue la produzione di prodotti da ricorrenza, che viene realizzata soprattutto da aziende medio-grandi specializzate, concentrate nel Nord Italia, in particolare nel Nord-Est.
DIFFERENZE PER SEGMENTO
Nel segmento dei lievitati da ricorrenza c’è una certa concentrazione, con i principali operatori come Bauli e Balocco che detengono oltre un terzo del mercato. Tuttavia, il settore è caratterizzato da una situazione di instabilità delle quote di mercato, soprattutto a causa delle attività promozionali e delle vendite sottocosto messe in atto dalla grande distribuzione che provocano spostamenti significativi dei consumi da un marchio all’altro a seconda dei periodi. Nel mercato del pane industriale, sono presenti numerosi operatori di piccole e medie dimensioni, mentre i mercati dei sostitutivi del pane e della biscotteria e pasticceria industriale sono più concentrati, con la presenza di un leader molto forte come Barilla.
GLI ELEMENTI COMPETITIVI
Come è immaginabile, la competizione è elevata e si basa sul prezzo, sulla capacità di stimolare la domanda attraverso continue novità di prodotto e, più in generale, su tutti gli elementi di differenziazione come il marchio, i formati, le ricette e il packaging.
La caratteristica comune a tutti i segmenti, ad eccezione dei prodotti da ricorrenza, è la dominanza incontrastata
Le aziende ricercano prodotti salutistici e funzionali innovativi, particolari,
Tabella 3. Principali player nazionali (in k €) (Fonte: Cerved)
del leader Barilla (e anche di Ferrero nei settori in cui è presente), che offre una vasta gamma di prodotti e sfrutta intensivamente le leve della promozione, della pubblicità e dell’innovazione.
Le altre aziende, come inseguitori, si trovano a una notevole distanza dal leader e la competizione per conquistare le quote di mercato residue è agguerrita.
Da segnalare l’elevata concorrenza nel segmento dei lievitati da ricorrenza; nella fascia alta del mercato l’immagine del marchio svolge un ruolo determinante insieme alla qualità intrinseca del prodotto, mentre nelle fasce medio-basse la concorrenza si basa principalmente sul prezzo. Un’alta intensità concorrenziale è presente anche nel settore del pane industriale, con alcune aziende che stanno incontrando difficoltà e accusano la scelta delle
grandi catene di supermercati e ipermercati di aumentare i punti vendita di pane fresco e di ampliare la loro offerta.
IL PESO DEI COSTI DELLE MATERIE PRIME
Il settore dei prodotti da forno e della pasticceria industriale è particolarmente sensibile all’andamento dei prezzi delle materie prime, che rappresentano una quota fondamentale dei costi di produzione (intorno al 50-55%). Nel 2022, c’è stato un forte aumento delle quotazioni delle materie prime: un incremento del 42% circa sia per il frumento biscottiero che per il frumento comunitario panificabile. Tuttavia, nei primi mesi del 2023, si è verificata un’inversione di tendenza, con una diminuzione delle quotazioni del frumento intorno al 7-9% rispetto alle quotazioni medie 2022.
A pesare su questa dinamica non è solo il conflitto in Ucraina: il settore è influenzato da sempre dalle oscillazioni delle quotazioni delle materie prime legate alla disponibilità globale di frumento tenero. A ciò si aggiungono le dinamiche della domanda da parte dei Paesi in via di sviluppo e i fenomeni speculativi, che nel corso degli anni hanno causato significative fluttuazioni dei prezzi dei cereali in generale.
I costi esterni (25-30% dei costi totali), comprendono le spese commerciali e distributive, gli incentivi alla forza vendita e le spese di promozione e pubblicità. La comunicazione è un elemento molto importante sia per supportare il lancio di nuovi prodotti, sia per consolidare l’immagine del marchio presso i consumatori finali.
Tabella 4. Principali player nazionali attività e marchi (Fonte: Cerved)
Azienda Gruppo Attività Marchi
GUIDO M. BARILLA E F.LLI SAPA Fam. Barilla
Forno dolce e salato. Opera anche in altri settori del largo consumo
BARILLA G. E R. FRATELLI SPA Fam. Barilla Forno dolce e salato. Opera anche in altri settori del largo consumo
FERRERO COMMERCIALE ITALIASRL Ferrero
FERRERO INDUSTRIALE ITALIASRL Ferrero
BAULI SPA Fam. Bauli
IRCA SPA Irca
Commercializzazione di merendine. Opera anche in altri settori del largo consumo
Mulino Bianco, Pavesi, Kamp’s, Harry
Mulino Bianco, Pavesi
Ferrero, Kinder
Merendine. Opera anche in altri settori del largo consumo Ferrero, Kinder
Ricorrenza, prodotti da forno Bauli, Doria, Croissanteria
Produzione di semilavorati per la pasticceria, gelateria e panificazione: cioccolato, preparati per dolci, per pani, per pizze, gelatine, dessert, oli, ecc
n.d.
A.LOACKER SPA Famiglia Loacker Wafer Loaker
COLUSSI SPA Colussi Forno dolce e salato Colussi, Antica Macina, Audisio
SAN CARLO GRUPPO ALIMENTARE SPA Gruppo Unichips Sostituti del pane, merendine, snack salati San Carlo, Pai
GALBUSERA BISCOTTI SRL Galbusera Biscotti, cracker, ricorrenza Galbusera, Buoni Così, Tre Marie
GALBUSERA SPA Galbusera Biscotti, cracker, ricorrenza Galbusera, Buoni Così, Tre Marie
NUOVA INDUSTRIA BISCOTTI CRICH SPA Nuova Industria Biscotti Crich Biscotti, cracker, wafer Crich
QUALITY FOOD GROUP SPA Nuova Industria Biscotti Crich Biscotti, cracker Delser
MORATO PANE SPA Aliante Equity 3 Pane morbido a fette Morato
BALOCCO SPA INDUSTRIA DOLCIARIA Balocco Ricorrenza, biscotti Balocco
DECO INDUSTRIE S.COOP.P.A. Deco Industrie Ricorrenza, forno dolce. Opera anche in altri settori del largo consumo
BALCONI SPA - INDUSTRIA DOLCIARIA Rowse Honey Limited
Merendine
Pineta, Loriana
Balconi
VICENZI SPA Vicenzi Forno dolce Vicenzi, Mr Day, Grisby
BOUVARD ITALIA SPA Bouvard International Torte pronte n.d.
MAINA PANETTONI SPA Maina Partecipazioni Ricorrenza
Maina
GRISSIN BON SPA Grissin Bon Forno salato Grissim Bon
STRATEGIE & SOSTENIBILITÀ
Sono soprattutto le aziende leader a puntare sull’innovazione di prodotto e sugli investimenti pubblicitari, adottando strategie che le differenzino dagli
operatori minori. La competizione, soprattutto tra marchi e private label, è molto intensa in un mercato in cui aumentare, o anche semplicemente consolidare, le proprie quote di mercato è
sempre più difficile. I ristretti margini e la spirale inflazionistica contribuiscono a rendere il tutto ancora più difficile. Le strategie delle principali imprese si concentrano principalmente sugli investimenti
pubblicitari per supportare il marchio e i prodotti, nonché in una incessante ricerca di novità nel prodotto, nelle ricette, nel packaging, nei materiali espositivi e nei gadget. Queste strategie mirano ad attirare l’attenzione del consumatore e a offrire prodotti con alto valore aggiunto o speciali, sfuggendo così alla competizione basata sul prezzo. A livello di “contenuto”, l’offerta è sempre più diversificata e cerca di andare sempre più incontro all’orientamento dei consumatori verso prodotti più sani, con l’eliminazione dell’olio di palma, la riduzione dei grassi, degli zuccheri e degli additivi. Anche se è difficile parlare di una strategia comune, è indubbio il fatto che venga data sempre più attenzione al tema della sostenibilità, alle certificazioni di filiera, ambientali e sociali, riducendo o sostituendo la plastica negli imballaggi e contenendo le emissioni durante la produzione, la logistica e la distribuzione, nonché utilizzando fonti di energia rinnovabile.
LA DOMANDA: LE TENDENZE
Quello di cui stiamo parlando è un mercato che tecnicamente viene definito “maturo”, il che si traduce in un tasso di penetrazione dei prodotti da forno e dei lievitati da ricorrenza tra le famiglie italiane superiore al 90% (un dato in linea con gli altri grandi paesi europei).
La domanda nel settore dei prodotti da forno e dei lievitati da ricorrenza è poco ciclica e sostanzialmente stabile (con l’elevato livello di penetrazione raggiunto, gli spazi di crescita sono piuttosto limitati); è evidente invece una forte sensibilità dei consumatori verso le novità e le promozioni.
L’analisi Cerved sottolinea che i consumatori manifestano un marcato interesse verso i prodotti che abbiano qualità o caratteristiche particolari, come specialità tipiche e regionali; prodotti ecosostenibili, che rispondono alle esigenze di una sem-
pre maggiore attenzione verso l’ambiente; nuovi formati e nuove ricette, tra cui prodotti salutistici, funzionali ed altamente nutrizionali. Questi prodotti, come quelli integrali, senza olio di palma, senza glutine o senza grassi, attirano particolarmente i consumatori che sono attenti a una corretta alimentazione. Non ultimo, da segnalare anche l’attenzione verso le novità nel packaging. La domanda nel settore è infine particolarmente sensibile alle promozioni, soprattutto a tagli di prezzo e omaggi nella confezione.
Questo studio sui Prodotti da forno e pasticceria industriale comprende le aziende che producono prodotti da forno dolci (biscotti, merendine, torte confezionate, fette biscottate etc.), prodotti da forno salati (pane industriale, grissini, cracker, pane in cassetta etc.) e lievitati da ricorrenza (panettoni, pandori, colombe). Non sono invece comprese le imprese specializzate nella produzione di prodotti di pasticceria e panetteria surgelata.
Il mercato dei prodotti da forno è composto da due macro-segmenti:
1 prodotti continuativi, consumati nell’arco di tutto l’anno (85% circa del mercato);
2 prodotti da ricorrenza, consumati esclusivamente in determinati periodi dell’anno (pandori, panettoni e colombe, il restante 15%). Nei lievitati da ricorrenza è inoltre importante la distinzione tra prodotti tradizionali e prodotti speciali (con forme originali, ricoperti, glassati, ripieni etc.).
Come è facile intuire sono molto nette le differenze tra i prodotti consumati nelle diverse occasioni di consumo. In estrema sintesi:
§ prima colazione: biscotti, fette biscottate e, in misura minore, merendine;
§ merenda e fuori pasto: merendine, biscotti in confezione monodose, snack;
§ pasti principali: pane industriale, grissini, cracker;
§ ricorrenza e regalo: alcune nicchie dei prodotti da ricorrenza e della pasticceria.

L’INDUSTRIA ALIMENTARE ITALIANA
FEDERALIMENTARE-CENSIS
Con 179 miliardi di euro di fatturato annuo, 60 mila imprese, 464 mila addetti e oltre 50 miliardi di export in valore in un anno, l’industria alimentare italiana rappresenta una componente di primo piano dell’interesse nazionale. Oltre a generare prodotti e occupazione, e quindi esprimere un forte potenziale economico, l’industria alimentare con la sua attività contribuisce al benessere psicofisico e alla qualità della vita degli italiani, dimostrando così anche un elevato valore sociale. Sono questi alcuni dei dati presentati presso la Camera dei Deputati, lo scorso 11 maggio e contenuti nel primo Rapporto Federalimentare-Censis, dal titolo “Il valore economico e sociale dell’industria alimentare italiana”. Dalla ricerca emerge anche come l’industria alimentare sia chiaramente protagonista all’interno della filiera del food italiano, che ha un fatturato totale di 607 miliardi di euro - comprendendo agricoltura, industria, distribuzione, ri-
storazione e altri settori interdipendenti in una logica B2B -, in valore pari al 31,8% se rapportato al Pil, con 1,3 milioni di imprese, 3,6 milioni di addetti e che costituisce quindi un patrimonio di interesse nazionale.
POTENZA ECONOMICA E ALTO VALORE SOCIALE
Nelle graduatorie dei settori manifatturieri italiani l’industria alimentare è al primo posto per fatturato, al secondo posto per numero di imprese, per addetti e per l’export in valore. In dieci anni il fatturato ha registrato in termini reali un incremento del 24,7%, il numero di addetti del 12,2% e il valore delle esportazioni del 60,3%. L’industria alimentare risponde a una spesa interna che, come quota del totale della spesa, è in Italia pari al 16,6%, come la Spagna, superiore a Francia (15,7%), Paesi Bassi (13,9%), Germania (13,4%) e media della UE a 27 Paesi (16,1%). Come si evince dal Rapporto, poi, l’86,4% degli italiani dichiara
di avere fiducia nell’industria alimentare italiana ed è una fiducia trasversale, che coinvolge il 93,8% degli anziani, l’84,2% degli adulti e l’81,6% dei più giovani. “L’industria alimentare italiana dà un poderoso contributo al Paese, sia come valore economico sia come valore sociale,” commenta Paolo Mascarino , Presidente di Federalimentare . “ Il settore è uno dei più dinamici e robusti dell’industria italiana e, dopo secoli di storia al fianco della nostra popolazione, vuole ancora essere impegnato a favore della crescita, nella consapevolezza di rappresentare un patrimonio nazionale nella produzione di alimenti di qualità, unici e con marchi riconoscibili. Quei prodotti del Made in Italy che, grazie all’industria alimentare italiana, costituiscono da sempre un vanto nel mondo.”
PATRIMONIO E WELFARE DEI CONSUMI
L’industria alimentare è oggi un patrimonio nazionale perché è sintesi di tradizione e contemporaneità, di radicamento

territoriale localistico e capacità di portare l’italianità nel mondo. Dalla ricerca emerge, infatti, una riconoscibilità dell’origine localistica, territoriale di marchi e prodotti che va di pari passo con la vocazione a conquistare i mercati con il Made in Italy e, in generale, l’“italianità”. La dimensione localistica e nazionale dell’industria alimentare italiana è molto apprezzata, infatti il 78,3% degli italiani, quota che resta alta trasversalmente ai territori, valuta molto positivamente che gli stabilimenti dell’industria alimentare siano localizzati in Italia, perché contribuiscono alla creazione di redditi e occupazione nei territori coinvolti e sono anche il segno di una permanenza su suolo
italiano di tanti marchi storici, alcuni addirittura iconici, decisivi per lo sviluppo locale e nazionale.
Inoltre, pur in situazioni di crisi e nell’attuale inflazione, emerge come l’industria alimentare abbia sempre garantito un’articolazione interna di prezzi che rende possibile l’inclusività, anche dei gruppi sociali più vulnerabili, nei consumi alimentari. Il 90,7% degli italiani dice che mangiare il cibo che preferisce è importante per il proprio benessere psicofisico. Pur non rinunciando al rigoroso controllo del budget familiare, il 63,4% degli italiani per alcuni alimenti acquista solo prodotti di qualità, senza badare al prezzo. Il 79%, pur praticando diete

soggettive nel perimetro di quelle tipicamente italiane, apprezza la disponibilità di nuove referenze nei punti vendita. È il senso del ruolo sociale di promozione del benessere e di welfare dei consumi alimentari.
Per Massimiliano Valerii , Direttore generale del Censis: “L’ingente contributo all’economia italiana dell’industria alimentare porta con sé anche un elevato valore sociale in termini di benessere diffuso, qualità della vita e coesione delle comunità locali. Ecco le ragioni della fiducia che gli italiani hanno nell’industria alimentare italiana, a cui riconosce di aver dato nel tempo un contributo essenziale alla conquista e alla tutela del
Nelle graduatorie dei settori manifatturieri italiani l’industria alimentare è al primo posto per fatturato, al secondo per numero di imprese e per numero di addetti, e anche per l’export in valore60 mila imprese e 464 mila occupati è componente di primo piano dell’interesse nazionale
L’86,4% degli italiani

ha fiducia nell’industria alimentare italiana
benessere. Il Rapporto FederalimentareCensis dimostra che l’intera filiera del cibo italiano costituisce oggi un patrimonio identitario: la sua tutela e la sua valorizzazione rientrano a pieno titolo nel perimetro dell’interesse nazionale”.
STILI ALIMENTARI E VALORI DEGLI ITALIANI
Il 42,1% degli italiani a tavola nel quotidiano si definisce un abitudinario, cioè mangia più o meno sempre lo stesso cibo, il 20,5% un innovatore a cui piace sperimentare alimenti e gastronomie nuove, il 9,2% un salutista che mangia sempre e solo cibo che fa bene alla salute, il 7% un appassionato, cura la spesa e gli piace cucinare, il 6,3% un italianista, vuole sempre e solo prodotti italiani, il 5,8% un convivialista, considera il cibo importante perché occasione per stare con gli altri, il 4,4% godereccio, perché mangia sempre quel che gli piace. Ma cosa mangiano gli italiani? Il 92,7% ha l’abitudine di mangiare un po’ di tutto senza vincoli particolari, solo il 7,1% si dichiara vegetariano e il 4,3% vegano o vegetaliano.
I CRITERI D’ACQUISTO
Emerge in maniera chiara come i criteri di acquisto siano molteplici (Tab. 1). Sono considerate come molto o abbastanza importanti per l’89,9% (di cui il 43,8% come molto importante) la possibilità di variare le pietanze tra pranzo e cena e tra i vari giorni della settimana e per l’89,2% (il 42% molto importante), la possibilità di rispondere a gusti, esigenze, preferenze di tutti i membri della famiglia. L’86,5% giudica importanti (di cui il 52% molto importanti) le pro-

mozioni, le offerte e gli sconti, il 73,5% (il 24,2% molto importante) la ridotta disponibilità di tempo per pensare e fare la spesa e l’87,9% (il 37,3% molto importante) la facilità con cui i prodotti si trovano nei luoghi di acquisto. Poi, l’84,3% reputa importante (di cui il 43% molto importante) che i prodotti non scadano subito, il 71,9% (22,4% molto importanti) la facilità e la rapidità per cucinarli; l’89,7% (di cui il 52,9% l’elevata importanza) reputa importante un’etichet-
tatura semplice, con informazioni comprensibili e verificabili in piena trasparenza, l’80,7% (il 28,4% molto importante) la fiducia nelle marche/aziende e il 68,2% reputa importante (il 26,9% molto importante) il contenuto calorico dei prodotti. È una gamma ampia e articolata di esigenze, altrettanti argomenti di una funzione multicriteria soggettiva che, spesso in modo automatico, guida le scelte di ciascun consumatore nei luoghi della spesa.
Sfida epocale affrontata dall’industria alimentare, anche come leva della sua trasformazione in linea con la contemporaneità, è quella relativa ai valori etici e sociali che per gli italiani sono importanti anche quando fanno la spesa o si mettono a tavola. Infatti, il 66,7% è pronto a rinunciare a prodotti che potrebbero essere dannosi per la salute, il 52,6% a quelli non in linea con criteri di sicurezza alimentare, il 43,3% a quelli la cui produzione e distribuzione non rispettano l’ambiente, il 35,6% a quelli per la cui produzione non sono tutelati i diritti dei lavoratori e dei fornitori.
Quanto sono importanti per Lei i seguenti aspetti nella scelta dei prodotti alimentari da acquistare?

Nello scenario geopolitico ed economico dei mercati estremamente variabile occorre che la spontanea spinta di imprese e imprenditori benefici sempre più di un contesto sistemico e di scelte politico istituzionali ai vari livelli pro-business, per affrontare in condizioni ottimali le sfide della nuova configurazione. È questo l’auspicio tracciato nel Report, in cui evidenzia come sia indispensabile un supporto politico sistemico in uno scenario in cui la globalizzazione sembra sempre più lasciare il passo a un’articolazione dei mercati globali tra due grandi entità:
§ quella composta dai Paesi occidentali, con il mondo anglosassone e la UE;
§ il polo centrato sulla Cina e intorno al quale tendono a gravitare colossi come l’India e anche la Russia.
Sono questi gli assi di un ordine geopolitico che condizionerà sempre più l’economia internazionale e con il quale le industrie dei vari Paesi devono fare i conti, dal lato della filiera degli approvvigionamenti dei fattori produttivi e da quello dei mercati di sbocco dei prodotti.
La necessità prioritaria individuata, anche per il nostro Paese, è quella di ri -
durre intenzionalmente in ogni ambito, quindi anche per un settore strategico come quello alimentare, il grado di dipendenza per l’energia, le materie prime, le tecnologie e anche il know-how organizzativo e imprenditoriale.
Una prima scelta strategica in questo senso è quella di riorganizzare le attività produttive decisive puntando a intensificare le relazioni economiche B2B e B2C con i Paesi UE e in generale europei, con quelli anglosassoni, USA in testa, e con i Paesi del Mediterraneo.
PACKAGING INTELLIGENTE GRAZIE AL CONFEZIONAMENTO IN LINEA
GRAZIE A IMPIANTI E LINEE AUTOMATICHE, IL CONFEZIONAMENTO DEI PRODOTTI ALIMENTARI È SEMPRE
PIÙ FLESSIBILE, EFFICIENTE, VELOCE E PERSONALIZZABILE
A SECONDA DELLE ESIGENZE PRODUTTIVE E COMMERCIALI
Il confezionamento è diventato negli anni un elemento fondamentale per le aziende alimentari. Il packaging infatti assolve a delle funzioni fondamentali, quali il contenimento del prodotto, la sua protezione da fattori esterni quali azioni meccaniche, come urti, contatto con altri oggetti esterni, ma anche da contaminazioni da parte di agenti chimici (acqua, umidità, aria) e biologici (microrganismi e macroparassiti), al fine di mantenerne la qualità inalterata per tutta la durata della shelf life.
Il packaging svolge anche una funzione comunicativa verso i diversi utilizzatori, grazie alle informazioni contenute in etichetta.
Le aziende alimentari si avvalgono sempre più di soluzioni automatizzate di imballaggio per la produzione di alimenti e bevande, in grado di ottimizzare il processo di lavorazione, anche grazie al confezionamento flessibile. Si tratta di macchine che hanno dalla loro la semplicità di utilizzo, l’efficienza di produzione e le elevate velocità di confezionamento.
Il fine linea è uno dei processi più automatizzati del settore alimentare. Il confezionamento automatico in linea è un sistema composto da un insieme di macchine automatiche che svolgono operazioni di confezionamento dei prodotti alimentari in sequenza continua e rapida. L’automazione viene sviluppata sia sulle macchine

Stefania Milanello Esperta in tecnologie alimentari e divulgatrice scientifica
per l’imballaggio primario che secondario e terziario. L’automazione del fine linea consente alle aziende alimentari una riduzione del costo di produzione, una maggiore velocità produttiva, un migliore controllo qualità dei prodotti confezionati e libera l’operatore da operazioni gravose. La linea di confezionamento si compone di diverse macchine integrate fra loro o da una singola macchina che si occupa di più fasi. Si possono trovare, ad esempio, supporti per le bobine dei materiali da confezionamento, confezionatrici verticali o orizzontali, stazioni di chiusura, trasporto delle confezioni etc. L’imballaggio in linea è corredato in genere di sistemi di etichettatura automatica.

L’automazione del fine linea consente alle aziende alimentari una riduzione del costo di produzione, una maggiore velocità produttiva, un migliore controllo qualità e libera l’operatore da operazioni gravose

Nel confezionamento automatico in linea, l’intervento dell’uomo si limita al controllo del funzionamento e alla gestione della linea attraverso pannelli comando. Controlla ad esempio il ricambio dei materiali per l’imballaggio del prodotto, come confezioni, etichette, tappi, si assicura che il prodotto sia integro, compila report sulla macchina e sui prodotti imballati.
SOLUZIONI DI AUTOMAZIONE PERSONALIZZATE
Il packaging ha assunto un ruolo strategico nella commercializzazione di un prodotto alimentare, grazie a design accatti-
IL FINE LINEA È UNO DEI PROCESSI PIÙ AUTOMATIZZATI DEL
vante e innovazioni tecnologiche che riguardano in primis forme e materiali. Anche per merito del packaging, le aziende alimentari possono diversificare i loro prodotti da quelli della concorrenza e fidelizzare i clienti, soprattutto in un mercato sempre più globale, competitivo e alla ricerca di prodotti personalizzati sulle esigenze dei clienti e delle mode, che porta a una maggiore frammentazione dell’offerta e delle vendite. Per stare al passo con il mercato, alle linee di confezionamento, agli impianti e alle singole macchine è richiesta una maggiore flessibilità operativa, insieme a costi contenuti, performance elevate in termini di precisione e velocità. Spesso le linee vengono integrate con robot per una maggiore automazione produttiva.
Per l’imballaggio primario di prodotti alimentari di diversi settori quali ortofrutta, panificazione, caseario, dolciario si utilizzano diverse macchine confezionatrici a seconda delle esigenze delle aziende e del prodotto da confezionare. Ci sono ad esempio confezionatrici orizzontali o verticali, riempitrici per piccole, medie ed elevate produzioni. Le confezionatrici orizzontali e verticali di tipo flow pack
è un sistema composto da un insieme di macchine automatiche che svolgono operazioni di confezionamento
Il confezionamento automatico in linea dei prodotti alimentari in sequenza continua e rapida
sono dotate di rulli per il traino e la saldatura, e saldatori per ottenere una busta chiusa e sigillata. Consentono cambi formato veloci e sono facilmente sanificabili e in grado di lavorare con diversi materiali da confezionamento come PE, PP, Film Laminati, PE+ Rete, PP+ Rete. Ci sono poi le avvolgitrici automatiche per un confezionamento pratico ed economico: consentono di avvolgere prodotti freschi e freschissimi, quali ortofrutta, gastronomia, carne, prodotti da forno. Il film estensibile protegge e preserva l’alimento, può essere stampato. Si tratta in genere di macchine abbinabili a sistemi di pesatura.
Esistono varie tipologie di macchinari anche per il confezionamento seconda-
rio e terziario. Alcuni hanno il compito di riempire i vuoti per proteggere i prodotti o ammortizzare gli urti, attraverso cuscinetti ad aria, oppure blocchetti di carta compressa a partire da risme o rotoli riciclati, utili ad esempio per prodotti fragili, quali bottiglie di vetro per vini o alcolici. Le macchine di chiusura imballano la confezione per proteggerla durante il carico e il trasporto, attraverso operazioni quali la nastratura completa delle confezioni e l’avvolgimento delle stesse tramite un film plastico. Le incartonatrici wrap-around avvolgono molti tipi di contenitori, come plastica, vetro, in cartoni fustellati intorno ai prodotti e sigillano la confezione con colla a caldo, processando fino a 100 cartoni al minuto.
I macchinari di ultima generazione utilizzano materiali ecologici, limitano gli sprechi di energia, gli scarti e di conseguenza i costi e consentono un controllo accurato dell’intero processo produttivo. I tipi di packaging utilizzati vanno dal film, al vassoio e alla falda accoppiati al film, ai cartoni etc.

SISTEMI PICK AND PLACE
I pick and place sono dei sistemi automatizzati di ultima generazione, utilizzati, come dice il nome, per il prelievo e il deposito di prodotti nelle confezioni. Si tratta di robot che ripetono queste operazioni in modo automatico per un ciclo programmato dall’operatore. Questi sistemi sono composti da un’intelaiatura fissa, montata su nastri trasportatori, in cui scorrono rispettivamente i prodotti da imballare e i cartoni da imballaggio. Il robot preleva il prodotto e lo deposita con ordine e delicatamente nel contenitore o contenitori diversi in un pacco, grazie a manipolatori dotati di pinze a presa. Esistono varie tipologie di pinze, anche modulate per quella determinata confezione, onde evitare oscillazioni e danni.
Grazie a questi robot il processo di fine linea, che riguarda il confezionamento, diventa più rapido e preciso. Essi sono dotati di sistemi di visione, che calcolano istantaneamente velocità e direzione dei nastri trasportatori, la quantità di prodotti trasportati, la disposizione, le forme, i colori etc. A tutto vantaggio della produttività aziendale.
ETICHETTATURA E CODIFICA
Difficile parlare di linee di confezionamento escludendo i sistemi di etichettatura e codifica. La marcatura deve essere precisa e permettere la lettura di tutte le informazioni presenti in etichetta, come il lotto, la data di scadenza, gli ingredienti, il nome del produttore e così via. Le aziende richiedo-
no tecnologie di marcatura e codifica che si adattino ai diversi materiali per imbal laggi, siano essi in plastica, vetro, cartone poliaccoppiato, barattoli in banda stagnata o lattine di alluminio, e alle diverse con dizioni operative, relative a temperatura e umidità, tipiche degli ambienti in cui si lavorano gli alimenti. Le etichettatrici, così come i marcatori devono essere flessibi li e in grado di adeguarsi velocemente ai cambi formato degli imballaggi e delle in formazioni che devono essere poste sulla confezione. Essendo inserite nella linea di confezionamento, le macchine per la mar catura e la codifica devono essere sanifi cabili e resistenti ai prodotti per la pulizia, nonché utilizzare inchiostri per alimenti, non tossici ed eco compatibili. Le soluzioni sul mercato sono molteplici e vanno dal le etichettatrici ve, stampa e applica datamatrix, così come etichette avvolgen ti, a sigillo, flow pack, doypack etc.

CONTROLLO DEL FINE LINEA
Spesso le linee di confezionamento sono dotate di sistemi di controllo, siano essi metal detector, raggi X o sistemi di visio ne artificiale. Essi consentono di elimina re i prodotti non conformi, per tipologia di confezione, mancanza o carenza di prodotto, metalli o altri oggetti estranei all’alimento o errori in etichetta, evitando costi e problemi di immagine dell’azienda, dovuti a eventuali richiami.
I rilevatori di contaminanti metallici segnalano la presenza di contaminanti ferrosi, non ferrosi e acciaio inox, anche nei prodotti confezionati. Vengono di norma installati su un nastro trasportatore e il sistema è dotato di espulsori a caduta o a getto d’aria, per eliminare la confezione non idonea all’immissione sul mercato. Possono essere installati anche prima che il prodotto sia confezionato. Altro control-
riempimento e l’integrità delle confezioni. Il sistema può essere applicato sia sui prodotti non confezionati che già confezionati per un controllo finale della merce. I sistemi di visione artificiale, quali telecamere, scanner e sensori ad alta risoluzione, possono essere utilizzati per verificare la qualità delle etichette, leggendo e verificando i codici, e degli imballaggi di qualunque materiale e forma, a velocità sostenute, senza interferire con l’alimento o la confezione, trattandosi di sistemi non invasivi. È possibile anche contare i prodotti, misurare i livelli di riempimento della confezione, la qualità dei contenitori o dei tappi. La confezione non conforme viene segnalata ed eliminata dalla linea. Essendo tutti questi controlli completamente automatizzati, è possibile registrare e conservare le informazioni che serviranno all’azienda sia come storico che come prova in caso di contestazione di un’eventuale non conformità.
COATING ATTIVI ANTIOSSIDANTI per preservare la qualità nutrizionale di finocchi minimamente processati
Marika Valentino, Elena Torrieri Dipartimento di Agraria, Università degli Studi di Napoli Federico II Membri del Gruppo GSICAFrutta e verdura sono un’importante fonte di nutrienti essenziali, come vitamine e minerali, oltre che una buona fonte di fibre e carboidrati. Tuttavia, quando sottoposti a processi di minima lavorazione (MPF&V) si deteriorano più rapidamente a causa dei danni provocati dalle operazioni di trasformazione (sbucciatura, lavaggio, affettatura, confezionamento, etc.). Le principali cause di alterazione sono correlate alla degradazione dei tessuti, all’imbrunimento della superficie di taglio, alla diminuzione del valore nutrizionale, allo sviluppo di odori non graditi e alla crescita di microrganismi (Davey et al., 2000; Kim et al., 2014).
Una tecnologia studiata per rallentare le cinetiche di alterazione dei prodotti alimentari è l’utilizzo di coating edibili
IN COLLABORAZIONE CON GSICA



Gruppo
tal quali o addizionati di sostanze attive ad azione antimicrobica o antiossidante. I coating edibili sono pellicole trasparenti costituite da polisaccaridi, proteine, e/o sostanze lipidiche, realizzate direttamente sugli alimenti per creare una barriera invisibile, inodore e insapore in grado di prolungare la vita commerciale dei prodotti (Baldwin et al., 1995). Possono svolgere un ruolo di barriera verso i principali gas, quali l’ossigeno o l’anidride carbonica, e agire da carrier di composti bioattivi, come per esempio sostanze antiossidanti o antimicrobiche, rispettivamente in grado di ritardare i processi di ossidazione o inibire la formazione di radicali liberi e inibire o ritardare la crescita di microrganismi (Siroli et al., 2015). Poiché la qualità degli alimenti cambia in funzione dei parametri di pro-
cesso e di conservazione, è importante utilizzare un approccio di modellazione dei processi di alterazione per avere la possibilità di controllare e/o predire l’evoluzione della qualità. In generale, le reazioni di degradazione della qualità sono modellate mediante un approccio cinetico, e le principali reazioni sono ben descritte da cinetiche di pseudo ordine zero, primo o secondo (Figura 1) (van Boekel, 2009). In letteratura esistono diversi lavori che evidenziano l’efficacia dei coating edibili nel preservare la qualità di MP F&V, ma nella maggior parte dei casi la sperimentazione prevede un approccio di tipo empirico che non aiuta a trasferire i risultati in condizioni sperimentali differenti. Inoltre, non esistono lavori sull’applicazione di coating edibili a finocchi minimamente processati.
Le principali cause di alterazione sono correlate alla degradazione dei tessuti, all’imbrunimento della superficie di taglio, alla diminuzione del valore nutrizionale, allo sviluppo di odori non graditi e alla crescita di microrganismi
Il presente lavoro rientra in un progetto Europeo di ricerca e innovazione finanziato nell’ambito del programma H2020 e finalizzato allo sviluppo di tecnologie non termiche per preservare la freschezza di F&V minimamente processata (https://www.shealthy. eu). Il Dipartimento di Agraria dell’Università
di Napoli Federico II ha il compito di sviluppare soluzioni di coating attivi (antiossidanti e antimicrobici) a base di biopolimeri da applicare a diverse categorie di F&V minimamente processati. Nel presente lavoro si riportano i risultati ottenuti nell’ambito della sperimentazione relativa all’applicazione di coating antiossidanti a finocchi minimamente processati. In particolare, il lavoro riporta i risultati relativi all’impatto del coating sulle cinetiche di decadimento della vitamina C e dei composti antiossidanti nel corso della conservazione.

I coating edibili sono pellicole trasparenti costituite
da polisaccaridi, proteine, e/o sostanze lipidiche, realizzate direttamente sugli alimenti per creare una barriera invisibile, inodore e insapore in grado di prolungare la vita commerciale dei prodotti
METODOLOGIE
La procedura per la preparazione e l’applicazione del coating è descritta da Valentino et al. (2020). In sintesi, i finocchi minimamente processati sono stati immersi per 2 minuti in una soluzione a base di caseinato di sodio (8%), glicerolo (0,8%) e gallato di propile (0,13 mg mL-1) e dopo asciugatura sono stati confezionati in vaschette di polipropilene avvolte con una pellicola di LDPE. Il prodotto senza coating è stato utilizzato come controllo. I campioni sono stati successivamente conservati a 15°C per 15 giorni
Ordine zero
Ordine primo Ordine secondo
e a diversi tempi di conservazione è stata valutata la capacità antiossidante e il contenuto di vitamina C. La modellazione matematica dei parametri nutrizionali è stata effettuata mediante regressione non lineare utilizzando il programma XLSTAT 16.0.
PRINCIPALI RISULTATI
Il decadimento della capacità antiossidante e della vitamina C dei finocchi MP è ben descritto da una cinetica di pseudo primo ordine (0,90< R2 < 0,97) (Figura
2, A e B). In tabella 1 sono riportate le costanti cinetiche stimate per i campioni controllo e i campioni ricoperti con il coating attivo. I campioni ricoperti con il coating attivo mostrano una cinetica di decadimento della capacità antiossidante ridotta del 50% rispetto ai campioni controllo. Infatti, per i campioni controllo, la capacità antiossidante si riduce del 60% dopo soli due giorni di conservazione, mentre per i campioni ricoperti con il coating attivo, un’analoga riduzione è osservabile dopo 5 giorni di conservazione. Nel caso del contenuto di vitamina C, le differenze sono minori con una riduzione della cinetica di decadimento
BIBLIOGRAFIA
§ Baldwin E., Nisperos-Carriedo M., Baker R (1995). Use of edible coatings to preserve quality of lightly (and slightly) processed products.
Critical Reviews in Food Science and Nutrition, 35:509-524.
§ Davey, M., W., van Montagu, M., Inzé, D., Sanmartin, M., Kanellis, A., Smirnoff, N., Benzie, I. F. F., Strain, J. J., Favell, D., & Fletcher, J. (2000). Plant L-ascorbic acid: Chemistry, function, metabolism, bioavailability and effects of processing. Journal of
Tabella 1. Costanti cinetiche dell’attività antiossidante e della vitamina C dei finocchi minimamente processati conservati a 15°C per 15 giorni
Capacità antiossidante
Controllo 0.304a±0.029
Attivo 0.147b±0.005
Controllo 0.073a±0.003
Vitamina C
Attivo 0.069b±0.001
del 5%. In generale, l’approccio cinetico si è mostrato efficace per descrivere il decadimento dei parametri nutrizionali del prodotto. Il coating attivo a base di caseinato di sodio e gallato di propile può essere una soluzione tecnologica per preservare la qualità nutrizionale dei finocchi MP. La ricerca è ancora in corso con l’obiettivo di studiare l’effetto della composizione del coating sulle cinetiche di decadimento per poter controllare il processo al fine di ottimizzare l’efficacia della tecnologia.
RINGRAZIAMENTI
Marika Valentino ringrazia il progetto SHEALTHY che ha supportato la borsa di dottorato nell’ambito del programma di ricerca e innovazione Horizon 2020 dell’Unione Europea, 2018-2020. Inoltre, ringrazia Commerciale Export (Pagani, Italia) per la fornitura dei finocchi utilizzati per questo lavoro.
the Science of Food and Agriculture, 80 (7): 825-860.
§ Kim, D. H., Kim, H. B., Chung, H. S., & Moon, K. D. (2014). Browning control of fresh-cut lettuce by phytoncide treatment. Food Chemistry, 159, 188192.
§ Siroli L., Patrignani F., Serrazanetti I., Gardini F., Lanciotti R (2015). Innovative strategies based on the use of bio-control agents to improve the safety, shelf-life and quality of minimally processed fruits and vegetables. Trends in Food Science and Technology, 46(2):302-310.
§ Valentino M., Volpe S., Di Giuseppe F. A., Cavella S., Torrieri E (2020). Active Biopolymer Coating Based on Sodium Caseinate: Physical Characterization and Antioxidant Activity. Coatings, 10 (8) 706, 1-12.
§ van Boekel., M., A., J., S. (2009). Kinetic Modeling of Reactions in Foods, Edited by Martinus A. J. S. van Boekel, CRC Press, Boca Raton, FL.
Normativa COOL come influisce sulla filiera alimentare
UN’INDICAZIONE DELLA SICUREZZA E DELLA QUALITÀ DEGLI ALIMENTI?
Determinare la provenienza di un prodotto alimentare non è così scontato quando le materie prime e gli ingredienti attraversano lunghi tragitti o vengono miscelati in prodotto prima di arrivare in sullo scaffale. Eppure, i consumatori sono più che mai interessati a capire da dove proviene il loro cibo e cosa c’è dentro. Man mano che le filiere alimentari diventano sempre più complesse sono necessarie regole condivise per attribuire un paese di origine a ciascun prodotto. Possono aiutare a definire dov’è stato fabbricato un prodotto e sono importanti per l’attuazione di altre misure di politica commerciale, tra cui preferenze commerciali, quote, misure antidumping e dazi compensativi. Ma questo aiuterà davvero i consumatori a rispondere alla domanda da dove viene “il mio cibo?”
CONFUSIONE...
Sfortunatamente, i consumatori spesso credono che l’etichettatura relativa a COOL (Country Of Origin Labeling) sia anche un’indicazione della sicurezza e della qualità degli alimenti. La realtà è che l’origine di un alimento non ha alcuna correlazione diretta o impatto sulla sicurezza o sulla qualità di un prodotto alimentare. Alcuni consumatori possono credere che il cibo fornito da un paese sia più sicuro o migliore che da un altro, ma questa è pura percezione.
...E BENEFICI
È la produzione del cibo, dal campo alla tavola, che governa la sicurezza e la qualità del cibo, non la sua origine.
Detto questo, l’etichettatura COOL aiuta a garantire buone pratiche di tracciabilità in tutto il settore alimentare. Il fatto che le organizzazioni seguano le normative COOL
 Paolo Bersighelli Business Developer Manager Food sector, BSI
Paolo Bersighelli Business Developer Manager Food sector, BSI

aiuta a garantire che le aziende dispongano di solidi sistemi di gestione e siano trasparenti e oneste su ciò che è contenuto nei loro prodotti, poiché devono essere in grado di dimostrare da dove provengono. Il potenziale per false affermazioni sulle etichette può portare a richiami, danni alla reputazione o persino alla chiusura di un’organizzazione, perciò è imperativo che le dichiarazioni COOL siano accurate e che venga prestata la massima attenzione sia ai fornitori che alle forniture.
COMPLESSITÀ
I requisiti COOL sono stabiliti dalla legislazione nazionale.
Anche se l’Organizzazione Mondiale del Commercio ha stabilito alcuni requisiti di alto livello, la legislazione nazionale (inclusa la normativa COOL) può differire da paese a paese. C’è anche confusione tra
L’ETICHETTATURA RELATIVA A COOL (COUNTRY OF ORIGIN LABELING) ÈCOOL aiuta a garantire buone pratiche di tracciabilità in tutto il settore alimentare

DA DOVE VIENE IL MIO CIBO?
l’etichettatura COOL e lo stato di “Indicazione Geografica Protetta” (IGP). L’etichettatura COOL richiede che l’origine di un prodotto alimentare sia chiaramente etichettata. L’IGP è un sistema di protezione per i produttori piuttosto che un obbligo legale di etichettare l’origine di un prodotto. Le denominazioni IGP sono utilizzate per proteggere alimenti locali come il Gorgonzola, la panna rappresa della Cornovaglia e la tequila. L’esempio più noto è Champagne. Affinché una bottiglia del rinomato vino riporti il nome Champagne sull’etichetta, il contenuto deve essere stato prodotto nella regione francese della Champagne.
COOL & WTO (Organizzazione Mondiale del Commercio)
Diversi anni fa, il Messico e il Canada hanno presentato un caso al WTO affermando che la legislazione COOL degli Sta-
BSI BRITISH STANDARDS INSTITUTION
BSI British Standards Institution – in qualità di ente di normazione – da oltre un secolo consolida best practice aiutando le organizzazioni in tutto il mondo a portare l’eccellenza al proprio interno e a costruire competenze e capacità per una crescita sostenibile. Fornisce servizi di certificazione, training e soluzioni di “customize assurance” a oltre 86.000 clienti in 193 paesi e diversi settori tra i quali il Food&Beverage.
ti Uniti era anticoncorrenziale nel caso dei prodotti a base di carne. Il WTO alla fine si è trovata a favore del Messico e del Canada, decidendo che la legislazione COOL discriminava ingiustamente le importazioni di carne e che la legge sull’etichettatura violava il requisito secondo cui gli Stati Uniti trattano le industrie del bestiame canadesi e messicane in modo non diverso da come trattano la propria. Di conseguenza, nel 2015 la Camera dei rappresentanti degli Stati Uniti ha votato per l’abrogazione dell’etichettatura COOL per manzo, maiale e pollo, evitando 3,6 miliardi di dollari in potenziali tariffe di ritorsione richieste da Canada e Messico. Non tutti sono rimasti delusi perché alcuni hanno sostenuto che la regola ha gravato sull’industria della carne statunitense. “Il programma non ha funzionato ed è ora di lasciarci alle spalle questo esperimento fallito una volta per tutte,” ha affermato il rappresentante Conaway durante il dibattito in aula al Congresso degli Stati Uniti e ha affermato che la normativa COOL non ha alcun impatto sulla sicurezza alimentare. Inoltre, è stato sottolineato dai legislatori che l’etichettatura obbligatoria degli alimenti COOL non riguarda la sicurezza alimentare e che,
indipendentemente dalla provenienza del cibo negli Stati Uniti, le normative rimangono in vigore per garantire la sicurezza e la tracciabilità.
D’altra parte, un sondaggio condotto dalla Consumer Federation of America ha rilevato che il 90% degli americani è favorevole a richiedere un’etichetta con il paese di origine sulla carne. È anche importante notare che il WTO non ha affermato che i confezionatori di carne americani non possono indicare il paese di origine sulle etichette sui propri prodotti. Diceva solo che il governo degli Stati Uniti non poteva richiederlo attraverso la legislazione. Pertanto, i confezionatori di carne domestici sono ancora liberi di apporre adesivi sulle loro confezioni di carne macinata e lombo di maiale che dicono che la carne proviene da animali nati, allevati e macellati negli Stati Uniti.
TRACCIABILITÀ E SICUREZZA ALIMENTARE

Sebbene non esista una correlazione diretta tra l’etichettatura COOL e la sicurezza e la qualità degli alimenti, è importante sottolineare che affinché il sistema COOL funzioni, i produttori di alimenti lungo tutta la catena di approvvigionamento alimentare devono disporre di sistemi di tracciabilità efficaci per garantire che sappiano cosa finisce nel loro prodotto finito. Quando i sistemi di tracciabilità sono completamente integrati e allineati con il sistema di gestione della sicurezza alimentare di un produttore, è molto probabile che migliori la sicurezza alimentare.
A causa di casi di frode alimentare di alto profilo come lo zucchero contaminato da fertilizzanti e gli scandali della melamina e della carne di cavallo, c’è una rinnovata attenzione alla tracciabilità degli alimenti.
Fortunatamente, l’abbondanza di nuove tecnologie in fase di sviluppo renderà tutto più facile per le aziende alimentari. L’etichettatura COOL è una sfida per l’industria alimentare. È spesso oneroso, difficile da applicare e complesso da perseguire. Ma, se la storia è un indicatore, la pressione dei consumatori alla fine supererà qualsiasi obiezione a COOL. Se i consumatori vogliono sapere da dove proviene il loro cibo dalle etichette delle confezioni alimentari, allora è probabilmente qui che andrà il mercato a lungo termine. Nel frattempo, spetta all’industria alimentare globale lavorare insieme per educare i consumatori su cosa c’è nel loro cibo, rendere le etichette il più chiare e facili da capire possibile, continuare a concentrarsi sul rafforzamento dei loro sistemi di tracciabilità e produrre prodotti sicuri che i clienti desiderano.

CONTROLLO DEI MICROFORI E DELLA CORRETTEZZA DELLE ETICHETTE
Un microforo nel packaging comporta una riduzione della shelf life dei prodotti, nonché conseguenze importanti sulla qualità. Negli alimenti confezionati in MAP (modified atmosphere packaging) provoca, ad esempio, la formazione di muffe, il cambio di colore e la variazione del sapore, portando a possibili richiami o ritiri, con conseguenze economiche e danni alla reputazione del brand. Per ovvia-
re a ciò, l’azienda di pasta fresca “Scoiattolo” ha introdotto la spettroscopia IR per il controllo in linea dei microfori sviluppata da Antares Vision Group con tecnologia FT System. Oltre al riscontro sui fori, la macchina consente di verificare la correttezza delle informazioni obbligatorie in etichetta (come data di scadenza o codice lotto) e nel codice a barre, la cui assenza renderebbe il prodotto invendibile. Un errore, infatti, nei dati obbligatori di etichettatura comporta il richiamo del bene o il ritiro dal mercato, con conseguenze sulla reputazione del brand, sulle spese di smaltimento e su quelle legali in caso di controversie.
Con l’applicazione di questa tecnologia l’azienda ha registrato una riduzione di non conformità dovute a microfori e a confezioni non correttamente saldate pari a circa il 45% (periodo settembre-dicembre 2022 vs settembre-dicembre 2021). “L’adozione di questo tipo di soluzioni è stata valutata
all’interno di un progetto più ampio che ha, come fine, il miglioramento dei flussi di produzione”, spiega Giacomo Tamborini, Innovation & Edp Manager di Scoiattolo.
La vera innovazione, specifica Tamborini, è stata l’introduzione dell’ispezione dei microfori nel packaging, che permette il controllo non distruttivo – senza la necessità di distruggere il campione, permettendo la ripetibilità della misura esattamente sullo stesso prodotto – della totalità delle confezioni, con un impatto positivo sulla sostenibilità. Un miglioramento netto, dunque, anche in termini di lotta allo spreco: “Avere statistiche puntuali relative agli scarti e alle relative cause ci permette di intervenire in modo tempestivo, riducendone le percentuali all’interno del reparto di confezionamento” conclude Tamborini.



L’ITER APPROVATIVO DEL PACKAGING ALIMENTARE

Come condividere, tracciare e velocizzare il processo
Il packaging del prodotto alimentare non è solo la “scatola” che consente la conservazione e la gestione del prodotto, ma è uno degli elementi fondamentali del marketing mix tanto da poter essere annoverata tra gli elementi da aggiungere al modello delle 4P (Product, Place, Promotion, Price).
Come coniugare gli obiettivi del marketing con gli aspetti legati alla sicurezza del prodotto, alle norme a tutela del consumatore e dell’ambiente? Come tutelare l’azienda dal rischio di ritiro dei prodotti a causa di packaging con dati non precisi o errati?
L’utilizzo di sistemi destrutturati quali e-mail, chat, telefono o la condivisione di file salvati su PC personali sono da contemplarsi tra le principali fonti di rischio di errori, di abbassamento delle responsabilità individuali nonché di allungamento dei tempi di rilascio del progetto relativo all’incarto. Tutti fattori che
possono comportare aggravi di costi, ritiro della merce dagli scaffali della GDO, sfiducia presso i consumatori nonché sanzioni amministrative e penali, nei casi più gravi (caso di errata dichiarazione di allergeni).
Per fronteggiare queste criticità è necessario ripensare a tutto il processo di raccolta e di elaborazione e approvazione dei dati tecnici del prodotto alimentare nonché alla successiva condivisione con tutti gli attori interni ed esterni del processo autorizzativo utilizzando sistemi di workflow specifici e definiti.
La piattaforma AYAMA di VIDA srl, già in uso presso importanti aziende alimentari nazionali, è lo strumento software ideale per raccogliere ed elaborare i dati tecnici del prodotto per poi renderli disponibili a sistemi workflow autorizzativi, necessari per supportare l’iter di approvazione del packaging da parte di tutti attori del siste-
ma, quali il marketing, lo studio grafico, i clienti (caso Private Label), società di traduzione, uffici legali, etc.
AYAMA è una soluzione software di tipo PLM volta a coadiuvare gli operatori dell’azienda già nelle fasi di definizione di R&D del prodotto, elaborazione dei dati nutrizionali (in diversi standard internazionali) e dei claim conformi alle disposizioni normative in materia alimentare, studio e monitoraggio della shelf life, fondamentale per la definizione TMC e modalità di conservazione e utilizzo del prodotto, verifica delle possibili cessioni dei MOCA nel prodotto, definizione dei dati da inserire nell’etichetta ambientale, fino alla predisposizione e aggiornamento della scheda tecnica, quale carta d’identità dell’alimento.
ETICHETTATURA AMBIENTALE DEGLI IMBALLAGGI

Le nuove Linee Guida

Per rendere disponibili le informazioni di etichettatura ambientale è possibile utilizzare uno strumento digitale che rimanda a una pagina appositamente dedicata
L’etichettatura ambientale degli imballaggi tiene desta l’attenzione degli operatori ormai da qualche tempo.
COSA DICE LA NORMA
Il Decreto Legislativo n. 116 del 3 settembre 2020 prevede che: “5. Tutti gli imballaggi devono essere opportunamente etichettati secondo le modalità stabilite dalle norme tecniche UNI applicabili e in conformità alle determinazioni adottate dalla Commissione dell’Unione Europea, per facilitare la raccolta, il riutilizzo, il recupero e il riciclaggio degli imballaggi, nonché per dare una corretta informazione ai consumatori sulle destinazioni finali degli imballaggi. I produttori hanno, altresì, l’obbligo di indicare, ai fini della identificazione e classificazione dell’imballaggio, la natura dei materiali di imballaggio utilizzati, sulla base della decisione 97/129/CE della Commissione [...]”
L’articolo 261 comma 3 del Codice dell’Ambiente prevede l’applicazione a ca-
GLI IMBALLAGGI DEVONO

INDICARE LA CODIFICA ALFANUMERICA PREVISTA
DALLA DECISIONE 97/129/CE
rico di chiunque immetta sul mercato imballaggi privi dei requisiti di etichettatura, di una sanzione amministrativa pecuniaria da 5.200 a 40.000 euro.
È a tutti noto il travagliato percorso della norma in esame, entrata in vigore nel settembre 2019 e poi sospesa ripetutamente fino all’ultimo D.L. del 30 dicembre 2021 (c.d. “decreto milleproroghe”) che aveva rinviato gli obblighi degli operatori fino al 31 dicembre 2022.
LE LINEE GUIDA
Peraltro viste le difficoltà interpretative sono intervenute prima le Linee Guida del Conai, poi il decreto ministeriale n. 114 del 16 marzo 2022, recante le “Linee Guida sull’etichettatura degli imballaggi ai sensi dell’art. 219, comma 5, del Decreto Legislativo 3 aprile 2006, n. 152”, che in buona parte riprendeva le posizioni espresse dal Conai.
Il suddetto decreto, nel corso dell’iter di notifica alla Commissione europea, aveva ricevuto alcune osservazioni volte a evitare ostacoli alla libera circolazione delle merci. In particolare era stato suggerito che nel testo fosse prevista la possibilità di utilizzare i canali digitali per veicolare le informazioni in maniera più chiara ed esplicita e non, come invece ipotizzato, attraverso il rinvio a una precedente circolare ministeriale.
Per adempiere all’obbligo di etichettatura il ricorso a canali digitali è sempre consentito ambientale degli imballaggi,
La questione si è risolta con l’emanazione del Decreto n. 360 del 28 settembre 2022 del Ministero dell’Ambiente e della Sicurezza Energetica (ex Ministero della Transizione Ecologica) che ha abrogato il precedente testo del DM 114/2022.
Il nuovo testo delle “Linee Guida sull’etichettatura degli imballaggi ai sensi dell’art. 219, comma 5, del Decreto Legislativo 3 aprile 2006, n. 152” recepisce infatti le osservazioni formulate dalla Commissione europea, ai sensi dell’articolo 5, paragrafo 2, della direttiva (UE) 2015/1535, con comunicazione TRIS/(2022) 02355, in tema di rafforzamento del ricorso alla digitalizzazione delle etichette con l’obiettivo di facilitare l’aggiornamento delle indicazioni ed evitare barriere al mercato interno.
L’art. 1 del D.M. in esame dispone infatti che: “3. Le informazioni obbligatorie di cui alle presenti Linee Guida sono rese con modalità tecniche, anche digitali, che garantiscono il rispetto del principio di libera circolazione delle merci”.
Tale versione delle Linee Guida potrà essere aggiornata o modificata periodi-
camente, alla luce di nuove disposizioni di legge (Nazionali e/o Comunitarie), nonché di nuove specifiche indicazioni, semplificazioni tecniche e modalità applicative dell’etichettatura, derivanti da

successive consultazioni e confronti con le Associazioni di imprese.
L’elemento più significativo del documento, molto atteso dagli operatori, è costituito dalla possibilità di far ricorso a strumenti digitali.
Impiego di strumenti digitali
Sotto tale profilo il nuovo testo delle Linee Guida precisa infatti che: “[...] è opportuno considerare che in alternativa all’apposizione fisica di tali informazioni sull’imballaggio, è possibile renderle disponibili tramite canali digitali a scelta (es. App, QR code, siti web), al fine di semplificare i processi produttivi, operativi ed economici delle imprese che immettono tali imballaggi in più Paesi dell’Unione Europea e assicurare quindi il rispetto dei principi della libera circolazione delle merci garantiti dal Trattato sul Funzionamento dell’Unione Europea. Qualora si utilizzino canali digitali, devono essere rese facilmente note e accessibili all’utente le istruzioni per intercettare le informazioni obbligatorie sopra descritte. Ulteriori approfondimenti in merito sono riportati nel box dedicato a
pagina 19 (in cui sono riportate le indicazioni del MITE sui casi particolari di cui alla Nota di Chiarimento del 17 maggio 2021 n.d.r.).
Sono state poi individuate alcune specifiche casistiche, per le quali risultano particolari limiti fisici e/o tecnologici, come nel caso degli imballaggi neutri, per i quali si forniscono, in queste linee guida, alcune alternative all’apposizione fisica dell’etichettatura sul pack, che prevedono l’utilizzo di supporti esterni. Approfondimenti in merito sono riportati nel box dedicato a pagina 18” (in cui sono riportate le indicazioni del MITE sui casi particolari di cui alla Nota di Chiarimento del 17 maggio 2021 n.d.r.).
Si ricorda che, in tema di ricorso al digitale il MITE, con Nota del 17 maggio 2021, aveva chiarito che: “Al fine di adempiere all’obbligo di etichettatura ambientale degli imballaggi, il ricorso a canali digitali è sempre consentito (es. App, QR code, siti web), in coerenza con il processo di innovazione tecnologica e semplificazione, aspetto oltretutto fondamentale previsto all’interno del Piano Nazionale di Ripresa e Resilienza (PNRR). Tali canali digitali possono sostituire completamente o integrare le informazioni riportate direttamente sull’imballaggio.
Questi strumenti possono essere utilizzati sia per facilitare la trasmissione delle informazioni obbligatorie lungo la filiera nei circuiti commerciali e industriali, sia per veicolare al consumatore finale la natura dei materiali di imballaggio e le indicazioni sul corretto conferimento. Qualora l’imballaggio sia destinato al consumatore finale, il soggetto obbligato è tenuto a riportare sull’imballaggio o sul punto di vendita, sia esso fisico o virtuale a cui il consumatore abbia accesso, le istruzioni per consentirgli di intercettare le informazioni ambientali obbligatorie tramite i canali digitali previsti (App, QR code, siti web, etc). In alternativa, tali istruzioni possono essere diffuse e rese accessibili per il mezzo di canali di

comunicazione tradizionali e digitali, attraverso campagne e/o iniziative promosse direttamente dalle aziende o con il contributo e la collaborazione delle associazioni maggiormente rappresentative del settore. Per rendere disponibili le informazioni di etichettatura ambientale è quindi possibile utilizzare uno strumento digitale che rimanda a una pagina appositamente dedicata a veicolare i contenuti sull’etichettatura ambientale che riguardano lo specifico imballaggio, a patto che l’accesso all’informazione specifica per l’imballaggio in questione risulti facile e diretta, e che detta informazione sia puntuale e non di difficile interpretazione. Si consiglia quindi di segnalare su tali canali, in modo evidente, l’imballaggio in questione, per rendere più facilmente reperibili e consultabili le informazioni al consumatore finale”.
CONCLUSIONI
In sintesi su tutti gli imballaggi (primari, secondari e terziari) i produttori devono indicare la codifica alfanumerica prevista dalla Decisione 97/129/CE:
§ Tutti gli imballaggi devono essere etichettati nella forma e nei modi che l’azienda ritiene più idonei ed efficaci per il raggiungimento dell’obiettivo, per il quale è sempre consentito il ricorso ai canali digitali (es. App, QR code, siti web), che possono sostituire completamente o integrare le informazioni riportate direttamente sull’imballaggio.
§ Sugli imballaggi destinati al consumatore devono essere presenti anche le diciture opportune per supportarlo nella raccolta differenziata.
§ È opportuno ricordare che le indicazioni in questione non si applicano ai farmaci e ai dispositivi medici per i quali la normativa di settore dispone già obblighi specifici, come chiarito dal Ministero nella recente risposta a un interpello.
IFS PEST CONTROL GUIDELINE 2022
Panoramica dei contenuti
Lo standard IFS FOOD versione 7 contiene un paragrafo dedicato al “Monitoraggio e controllo degli infestanti” (4.13). In altre sezioni dello standard, sono inoltre presenti numerosi riferimenti diretti o indiretti alle attività di gestione degli infestanti nell’ambito dei siti certificati.
Il paragrafo 4.13 è composto da 7 requisiti che, seppure numericamente inferiori rispetto all’altro standard di riferimento BRCGS Food ed. 9, coprono grossomodo le stesse aree di attività, confermando un forte interesse sulle attività di Pest Management. Del resto, le deviazioni/non conformità relative al pest control sono comunemente riportate dagli auditor di entrambi gli standard.
Per queste ragioni, al termine del 2022, IFS ha messo a disposizione una ricca e completa linea guida (“IFS Pest Control Guideline version 2”) allo scopo di fornire ai siti certificati IFS uno strumento utile sia per comprendere al meglio i requisiti dello standard, sia per informare sugli attua-


li sviluppi e orientamenti del settore del pest management.
IFS PEST CONTROL GUIDELINE VERSION 2
Come specificato anche nello stesso documento, la linea guida non è un documento normativo e la sua implementazione non è obbligatoria, anche considerando che le attività di pest control in senso lato sono soggette a regolamentazioni differenti nei vari Paesi e di questo è necessario tenerne conto.

L’impatto ambientale
La linea guida considera una serie di modifiche di contesto internazionale, dal punto di vista normativo, economico, della sostenibilità e della digitalizzazione/tecnologia, che coinvolgono naturalmente anche il settore agroalimentare e del pest management; tra questi il “Green Deal” dell’Unione Europea che spinge in maniera significativa il settore industriale a essere più sostenibile anche dal punto di vista dell’impatto ambientale.
LA SFIDA DELL’EFFICACIA
TRATTAMENTI DEVE CONVIVERE CON LA NECESSITÀ
DELLA RIDUZIONE DEI RISCHI AMBIENTALI
Tali sviluppi coinvolgono anche il tema del pest management, dapprima nel “campo” (difesa integrata e biologica), ma successivamente anche negli ambienti delle industrie alimentari. Da un lato, vi è la sfida dell’efficacia dei trattamenti e dei controlli necessari; d’altro canto, la necessità di prevenire e ridurre tutti i rischi ambientali, anche attraverso nuove tecniche, maggiormente sostenibili e sicure, considerando anche gli strumenti digitali ormai disponibili. Tutti questi elementi, spingono in maniera netta verso la direzione dell’IPM (Integrated Pest Management), ovvero della gestione integrata degli infestanti. La linea guida riporta numerosi esempi di gestione dei roditori, sebbene il documento sia riferibile alla gestione di tutti
gli infestanti di interesse per l’industria alimentare; nella sua stesura, essa ha avuto anche il fattivo contributo di una società tedesca specializzata in sistemi digitali per la lotta ai roditori, nonché il contributo italiano di ANID (Associazione Nazionale delle Imprese di Disinfestazione).
IPM, strategia ottimale Scopo del presente contributo è quello di fornire una panoramica esemplificativa e non esaustiva sui contenuti del documento. Dopo una breve capitolo introduttivo, la linea guida affronta le novità del settore, occupandosi di IPM, con una panoramica dei nuovi elementi che incoraggiano questo approccio, per raggiungere obiettivi di sostenibilità ed efficienza.
dovrebbe essere documentato e oggetto di miglioramento continuo
L’approccio integrato e sostenibile agli infestanti
Sebbene venga chiaramente ricordato che l’IPM non sia una novità assoluta, esso viene comunque definito quale strategia ottimale per gestire gli infestanti utilizzando un’ampia varietà di metodi di controllo che tendono a ridurre l’utilizzo dei pesticidi. In sostanza l‘IPM è chiamato a identificare le fonti dell’infestazione e le condizioni che possono contribuire allo sviluppo della stessa, a monitorare l’attività degli infestanti e a focalizzare le attività di controllo alle fonti dell’infestazione. Alla base della piramide dell’IPM, sono presenti tutte le pratiche e le misure preventive e culturali, seguite dall’applicazione di metodi fisico-meccanici, metodi di controllo biologico seguiti, infine, dall’uso dei biocidi (pesticidi in senso lato). L’uso dei pesticidi dovrebbe essere ridotto ai casi strettamente necessari e devono essere applicati secondo le condizioni di etichetta. Qualora i prodotti chimici siano applicati con regolarità la linea guida richiede che il piano di azione sia revisionato o comunque rivalutato, al fine di individuando metodi meno impattanti. I pesticidi devono essere sempre impiegati attuando tutte le misure di mitigazione dei rischi disponibili.
Naturalmente, l’applicazione delle tecniche IPM può avvenire con successo solo tramite una forte cooperazione fra l’impresa alimentare e il fornitore esterno di servizi, in quanto tutta una serie di aspetti gestionali e strutturali sono certamente in carico al sito.

Uso sostenibile dei pesticidi
Questo approccio è calato perfettamente nel contesto più ampio dettato dal “Green Deal” europeo e della strategia “Farm to Fork” che ne è parte integrante, con lo scopo di stabilire sistemi alimentari sostenibili per persone sane, società sane e un pianeta sano. L’uso sostenibile dei pesticidi, quindi, rappresenta un punto cardine anche supportato dai recenti sistemi digitali di monitoraggio (24/7) e controllo disponibili sul mercato, che possono contribuire a razionalizzare gli interventi con pesticidi (in particolar modo dei rodenticidi: tali metodologie sono per lo più orientate al controllo dei roditori).
Nel capitolo sono forniti numerosi esempi di misure di controllo “culturali/gestionali” e quindi non invasive (per es.
posatoi per uccelli rapaci predatori di roditori, installazione di reti anti-insetto alle finestre, gestione degli scarichi fognari, etc.), di tipo fisico-meccanico con trappole, di tipo biologico (impiego di insetti antagonisti “utili” per la gestione di alcuni parassiti delle derrate), etc. In questo contesto, l’applicazione delle GHP e delle GMP è naturalmente cruciale e anche a esse viene dato ampio spazio. A proposito dei rodenticidi, un’ampia parte del capitolo descrive i biocidi e l’uso sostenibile dei rodenticidi, non destinati a un uso permanente e alle tecniche alternative o complementari disponibili sul mercato.
A tale riguardo, viene incoraggiato fortemente l’uso di strumenti digitali, compreso l’uso di fototrappole. Tra i vari spunti di interesse si cita una considerazione: secondo gli esperti, oltre l’80% di tutte le postazioni che vengono controllate sono regolarmente nelle stesse condizioni della visita precedente. Con le telecamere IoT supportate dall’Intelligenza Artificiale, questi controlli di routine potrebbero essere evitati e il tempo a disposizione potrebbe essere impiegato per un maggiore supporto al cliente. Inoltre, i riscontri digitali possono dare modo di intervenire più rapidamente e in maniera più efficace.
L’approccio integrato e sostenibile agli infestanti dovrebbe essere documentato e oggetto di miglioramento continuo.
Come implementare l’approccio integrato
Il capitolo successivo fornisce, infine, un approccio raccomandato per implementare l’approccio integrato in funzione dei requisiti di IFS.
Il documento prosegue facendo diretti riferimenti ai requisiti della versione Food versione 7, con spiegazioni e interpretazioni degli stessi. Per ogni requisito è quindi disponibile un chiaro commento esplicativo e sono ripor-
tate situazioni riscontrabili durante gli audit, con quesiti specifici che potrebbero essere posti in tale sede, indicando cosa potrebbe essere valutato, corredato da esempi di Non conformità di tipo maggiore. A tal riguardo, a titolo esemplificativo, possono generare questa tipologia di rilievi i seguenti riscontri:

§ assenza di gestione degli infestanti;
§ aperture nelle pareti che possono facilmente consentire l’accesso degli infestanti;
§ contaminazione del prodotto alimentare a cause di esche non tenute sotto controllo;
§ messa a rischio della sicurezza di un prodotto dovuto all’uso scorretto o improprio dei prodotti chimici;
§ presenza di un’infestazione in corso e non gestita;
§ mancanza di formazione della persona interna all’impresa alimentare designata per la supervisione delle attività di pest control;
§ assenza di evidenza di svolgimento di controlli e ispezioni periodiche;
§ assenza di documentazione relativa all’implementazione di azioni correttive (potrebbe generare un KO);
§ posizionamento di trappole, comprese le lampade UV, in modo da mettere a rischio il prodotto esposto;
§ rimozione non tempestiva dei roditori catturati dalle trappole;
§ assenza di controlli in ingresso alla merce e conseguente diffusione di un’infestazione;
§ assenza di una valutazione periodica del trend, soprattutto in caso di infestazioni persistenti o che indicano dei peggioramenti significativi e necessità di azioni urgenti.
Sono inoltre ripresi gli ulteriori requisiti di IFS FOOD Versione 7 distribuiti in altri paragrafi dello standard che riguardano la gestione degli infestanti (gestione dei veicoli, delle finestre, delle porte e dei portoni, delle aree di carico/scarico).
GLI ALLEGATI
Analisi e valutazione dei rischi
A seguire, la linea guida mette a disposizione una serie di allegati, anch’essi molto utili per la comprensione e l’attuazione degli standard. Infatti, l’allegato 1, riporta una sintetica rassegna sui requisiti relativi alla gestione degli infestanti disponibili negli altri standard IFS, indicando che i principi descritti nella linea guida del 2022 sono di fatto applicabili a tutti gli standard.
L’“Annex 2” è dedicato all’analisi dei pericoli e alla valutazione dei rischi specifiche per ciascun sito. Si ricorda che tutte le misure di pest control devono essere basate su tale attività preliminare di valutazione, considerando l’ubicazione degli edifici e del sito, le misure preventive in essere, i mezzi di controllo disponibili attraverso l’applicazione dell’IPM, le tipologie di infestanti di interesse, il monitoraggio e la documentazione (anche digitale). Tra i passaggi cruciali di questo allegato vi è la forte spinta alla cooperazione tra l’impresa alimentare e il fornitore esterno di servizi di pest management nell’elaborazione di tali documenti e nella gestione di tali attività. La linea guida afferma che entram-
be le parti debbano svolgere una valutazione dei rischi, ciascuno per gli aspetti di propria competenza, che possono impattare sulle attività complessive di gestione degli infestanti. Sono forniti esempi di valutazione dei rischi, impiegando le matrici di probabilità/ gravità e conseguente calcolo del rischio e relative misure di gestione, anche mediante rappresentazioni grafiche in planimetria. La linea guida incoraggia a definire per ogni area del sito una definizione specifica, le frequenze di intervento, gli specifici infestanti di riferimento, le tipologie di dispositivi da impiegare e le rispettive quantità dislocate nel sito.
Tra gli altri e numerosi elementi considerati, la linea guida ricorda che lo scopo delle operazioni basate sulle tecniche IPM è quella di ridurre la probabilità di presenza di infestanti, in quanto difficilmente il parametro della gravità potrà risultare modificabile. A ogni modo, per raggiungere tale obiettivo, è necessario migliorare gradualmente tutte le attività di gestione infestanti, partendo dalle attività di prevenzione. La valutazione del rischio necessita, naturalmente, di riesami periodici.
Misure di segnalazione remote
Nel terzo allegato disponibile, alla luce della diffusione sul mercato di numerosi standard IoT legati alle trappole e alle misure di segnalazione remote, vengono elencati gli standard diffusi (a titolo esemplificativo), con diverse valutazioni tecniche, tra cui i punti di forza e i rispettivi punti deboli.
La formazione del personale
In “Annex 4”, la linea guida riporta elementi utili riguardo la formazione e le qualifiche del personale. Se da un lato è necessario rifarsi alle eventuali disposizioni nazionali – se disponibili – riferite alla formazione specifica per il settore della disinfestazione (in Italia, aspetto di fatto non normato), si incoraggia in ogni caso a sviluppare, attraverso formazione appropriata – di carattere volontario – le competenze necessarie per gestire tali attività. Si ricorda che IFS richiede espressamente che una persona interna all’impresa alimentare sia formata e responsabile delle attività di pest management, anche qualora queste siano appaltate all’esterno. Questa persona dovrebbe essere in possesso di una formazione relativa a quali siano le aree dell’infrastruttura in cui vi possa essere attività da parte degli organismi infestanti, ai materiali (materie prime, prodotti finiti, packaging, etc.) che potrebbero essere oggetto di infestazione/contaminazione, alla mappa delle trappole, alle tipologie di misure di controllo applicabili (compresi i controlli sulle merci in ingresso), all’analisi degli andamenti, delle azioni intraprese e della loro gestione temporale e alla documentazione/registrazione disponibile.
Il contratto
L’allegato 5 fornisce una panoramica sui contenuti di un contratto di servizi di
pest management, in caso di affidamento all’esterno di tali attività, esortando sempre alla cooperazione tra le parti. Sono indicati i punti specifici che dovrebbero costituire un contratto tipo, indicando:
§ le parti coinvolte;
§ una premessa che chiarisca gli scopi delle attività;
§ il contesto legale, al fine di assicurare la conformità con le normative di riferimento;
§ l’analisi dei pericoli, includendo gli infestanti di interesse, le condizioni del sito e dei suoi dintorni e i prodotti lavorati nel sito;
§ le specifiche tecniche e i termini del servizio;
§ la durata del contratto e i termini dello stesso, il periodo di preavviso, compresa la gestione di documenti aziendali specifici e generali e la riservatezza tra le due parti;
§ le figure chiave e i dati per valutarne le performance;
§ la responsabilità, comprese la copertura assicurativa (ad esempio, assicurazione responsabilità civile) e la responsabilità per inadempimento delle prestazioni pattuite a tutela contro i rischi imprenditoriali.
Come scegliere un’impresa di disinfestazione
In “Annex 6” sono disponibili importanti riferimenti per la valutazione dei fornitori esterni di servizi. Lo standard in sé non descrive un metodo particolare per la valutazione dei tecnici e delle imprese che erogano servizi di disinfestazione.
Tuttavia, ogni servizio esterno di gestione delle infestanti deve essere basato su un’ispezione iniziale, su una valutazione dei rischi, tenendo in considerazione il contesto legale, i pericoli, le misure di sicurezza e gli obblighi/requisiti del cliente. Una volta avviato un servizio di gestione infestanti esterno, esso dovrà essere
implementato e documentato in maniera adeguata valutando anche l’efficacia dei servizi. Per supportare la valutazione dei fornitori esterni sono disponibili sul mercato europeo e internazionale diversi standard, adottabili e certificabili dalle imprese di disinfestazione. Tra questi, la linea guida cita EN 16636 (in Italia UNI EN 16636), ISO 22000 oltre alle ben note ISO 9001 e ISO 14001. La conformità con questi standard sarà verificata attraverso valutazioni indipendenti svolte da organismi di certificazione accreditati.
Sicurezza alimentare
Il documento si chiude con l’allegato 7. In questa sezione della linea guida viene ribadito che per soddisfare interamente i requisiti IFS è necessario che tutti i requisiti legali debbano essere presi in considerazione compresi i requisiti locali. In “Annex 7”, quindi è riportata una sintesi delle principali norme europee che riguardano sia gli aspetti di igiene degli alimenti e sicurezza alimentare ma anche ma anche le normative legate alle sostanze chimiche, tra cui il Reg. Biocidi (UE) 528/2012 e il cd. regolamento “REACH” (CE) 1907/2006. A riguardo delle normative nazionali e i codici di buona pratica è necessario poi considerare le norme relative alla protezione degli animali selvatici, relativa ai servizi di disinfestazione e ad altre norme applicabili. Sono altresì prese in considerazione altre normative e linee guida eventualmente applicabili come la già citata EN 16636 e altre linee guida settoriali del settore alimentare.
IN CONCLUSIONE
Il corposo documento rappresenta dunque un importante punto di riferimento per la gestione degli infestanti, con un respiro che di fatto supera i confini definiti dagli standard IFS e può certamente essere preso in considerazione come riferimento sia per l’applicazione di altri standard GFSI, sia dell’attività di pest management anche in altri settori.

AUDIT NELL’INDUSTRIA ALIMENTARE
I vantaggi dell’ERP CSB-System

La salute e l’ambiente non possono più essere considerati in maniera disgiunta. Per l’industria alimentare questo introduce l’importanza delle certificazioni. L’ERP CSB-System semplifica quest’attività, perché offre una gestione integrata delle informazioni, facilita le attività ricorrenti in vista di un audit e consente una presentazione strutturata delle informazioni rilevanti. Esistono vari tipi di controlli prescritti dalla normativa in campo alimentare: certificazioni come l’IFS Food servono principalmente a garantire la qualità e la sicurezza alimentare. Procedure come l’HACCP identificano e analizzano i potenziali pericoli e i punti critici di controllo nella gestione dei processi; altre certificazioni sono volontarie (ad es. CO2-Label, Halal, Kosher, etc.). Tutte rappresentano un ingresso privilegiato nel mercato della GDO.

QUALITÀ DEI PRODOTTI GARANTITA
I responsabili aziendali, in collaborazione con gli esperti CSB-System, individuano i cosiddetti Critical Control Points ai quali collegare postazioni fisse o eventuali dispositivi mobili per il rilevamento dati. Da qui le informazioni sono direttamente inserite, registrate e analizzate nell’ERP CSB-System, senza soluzione di continuità. Processi, come pesatura, miscelatura, lavorazione, riempimento e confezionamento sono sincronizzati con il CSB Quality Management (QM) e Labor Information System (LIMS), che registra i passaggi critici in maniera precisa seguendo i checkpoint precedentemente definiti.
GESTIONE DI AUDIT E CERTIFICAZIONI CON UN UNICO ERP

Qualora ci siano degli scostamenti dai parametri prestabiliti, è il CSB-System a comuni-
care automaticamente la non conformità al responsabile della qualità, per poter avviare poi le azioni correttive. In ogni caso, i dati raccolti confluiscono nella Gestione Certificazioni CSB presente nel modulo CSB QM e LIMS, a sua volta completamente integrato nell’ERP CSB-System. Vale la pena menzionare che grazie alla CSB Quality App è pos-
sibile richiamare e inserire i risultati dei test ovunque e da qualsiasi dispositivo, in modo flessibile e in linea con le esigenze di ognuno. L’app è integrata nell’ERP ed è disponibile in più lingue.
TROPPO FACILE DIRE… QUALITÀ
Prima di parlare dei test rapidi, è opportuno fare una breve riflessione sul settore in cui ci troviamo a operare, il quale è complesso e in continua evoluzione. È necessario comprendere le sfide che il mercato ci pone per poter rispondere al meglio a ogni esigenza.
Al giorno d’oggi sono presenti in commercio un gran numero di prodotti e la scelta per il cliente risulta sempre più difficile. L’acquirente è sicuro di avere tutte le informazioni necessarie per fare una scelta consapevole?
Oppure si lascia guidare solamente dal prezzo vantaggioso, accontentandosi di tamponare momentaneamente il problema senza darvi soluzione?
È sotto gli occhi di tutti il crescente numero di prodotti richiamati o che presentano criticità per la salute del consumatore. Questi episodi possono presentare un danno d’immagine molto importante per l’azienda, con una perdita di fiducia da parte del consumatore. In quest’ottica, è opportuno basare le scelte aziendali in funzione della sicurezza e non solamente a favore del risparmio. I problemi al giorno di oggi devono essere risolti con la conoscenza, con i mezzi appropriati e affidandosi a sistemi e metodi di qualità. Recentemente si sta andando a diffondere sempre più nella mangimistica l’impiego della bentonite, un tipo di argilla idrofila usata come assorbente attivo per le micotossine.
Non si conoscono gli effetti sull’animale in caso di somministrazione a lungo termine. Siamo sicuri che sia la scelta giusta per la salute dell’animale e per la sicurezza alimentare?
Oggi sul mercato ci sono diversi test rapidi per rilevare residui nel latte, alcuni sono proposti a un prezzo molto accattivante, tuttavia solo pochi di questi riescono in modo affidabile a determinare e rilevare le sostanze residue, nel rispetto dei limiti MRL EU.
Da oltre 20 anni, Alitest “Soluzioni di Qualità” opera nel settore lattiero-caseario fornendo su tutto il territorio nazionale test di altissima qualità. Le esigenze aziendali oggi
richiedono test che garantiscono rapidità, semplicità di utilizzo e affidabilità. Il problema non è quante sensibilità sono dichiarate, ma come vengono rilevate. Il confronto può essere effettuato solo tramite le metodiche originali rilasciate dalla casa produttrice. Nel caso in cui non siano rispettati i limiti MRL EU, non c’è garanzia di un prodotto finito conforme. Solo con la scelta di un test di qualità è garantita sicurezza e tranquillità.
Alitest ha a disposizione una famiglia completa di test rapidi per ogni esigenza:

§ Test singoli: Betalattamici, Tetracicline, Sulfamidici, Chinoloni, Amminoglicosidi, Macrolidi, Cloranfenicolo, Enrofloxacina e Aflatossina M1 Quantitativa.
§ Test Combinati: Beta/Tetra - Beta/Tetra/ Sulfa - Beta/Tetra/Sulfa/Chinoloni - Beta/ Aflatossina M1 qualitativa.

Affidati ai prodotti Charm che sono diffusi sul mercato internazionale per oltre il 75%. Chi investe in sicurezza, vince sempre. Noi ci crediamo.

CULTURA IN TAVOLA
Dove e quando si parla della domanda del mercato sovente scatta, inesorabile, la trappola del nuovo prodotto multifunzionale. I funzionari della ricerca e sviluppo, adombrando la potenzialità del brevetto internazionale, si assicurano la scrivania almeno per la durata del progetto. I dirigenti hanno quattro/cinque diapositive da portare alle riunioni del piano superiore. I membri del Board hanno un decente programma da mostrare agli azionisti… In breve, la macchina gira.
Anche se tutti sanno che nel comparto alimentare – locale o globale che sia – il tempo di realizzazione del nuovo prodotto è solo una piccola frazione del tempo necessario affinché diventi un acquisto abitudinario. Per questo parlo di trappola.
Il mercato alimentare è diverso dal digitale e dalla telecomunicazione, settori nei quali in poco tempo sono entrati in funzione miliardi di elaboratori e telefonini, più o meno smart. Se invece contiamo gli anni dal matematico, crittografo e filosofo Alan Turing, di acqua sotto i ponti ne passò parecchia.
L’alimentazione si impara – come la religione – sulle ginocchia della madre e cambiamo approccio alimentare solo per estrema necessità, ma la cucina della nonna, comunque, sarà sempre la migliore!
Ma tornando alla multifunzionalità alimentare e, non volendo mentire a noi stessi, possiamo ammettere che la maggior parte dei nuovi prodotti introdotti con successo nel mercato erano rispettosi della cultura alimentare e facilitavano la loro fruibilità. In molti casi, offrivano miglioramenti sotto il profilo del confezionamento, della serbevolezza o delle qualità sensoriali.
Quindi è molto bello parlare di multifunzionalità, ma molto più pragmatico è parlare di cultura. Perché lo stile di vita, lo stile alimentare è un tema culturale. Ne avete conferma da come alcuni camerieri o avventori di ristoranti maneggiano certe bottiglie di vino. A volte vien da piangere, un conto è avere i soldi per pagare vino e companatico, altro è la cultura di preparare, servire e apprezzare la buona tavola. Perché tutta la filiera agroalimentare prima o poi finisce in tavola.
E in tavola ci vuole cultura, o no?

Volete dire la vostra?
Scrivete a: redazione.food@quine.it
Lo stile alimentare
è un tema culturale
Diamo colore alla vostra applicazione!
Pressostato compatto con indicazione a 360° della condizione d’intervento www.vega.com/vegabar

256 colori
Selezionabile
individualmente:
Misura in corso Commutazione del sensore Malfunzionamento nel processo
